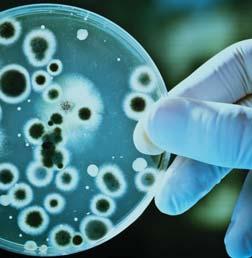

Mais conforto, economia e alta confiabilidade em uma ampla faixa de opções

1º chiller com condensação a ar e compressor parafuso de velocidade variável do Brasil


FALTA
À MANUTENÇÃO DE SISTEMAS DE AR CONDICIONADO E ELÉTRICA, ENTRE OUTROS ESTÃO NO TOPO DOS CAUSADORES DE SINISTROS.

Venda de eletrodomésticos cresce 36%. Alta foi puxada pela demanda de condicionadores de ar e ventiladores.
Fabricante japonesa inaugura
CT em Salvador (BA)
Em evento aberto para o setor, marca traz novidades 2024 e anuncia Tiago Liefert como embaixador da marca.
Celebra 100 anos
Com 10 plantas e várias unidades de negócios atuantes nos cinco continentes, o Grupo Mayekawa mostra porque é um gigante do setor do frio
44 anos de Brasil
Philco promove treinamento técnico
Empresa divulga calendário de treinamento e capacitação exclusivo para instaladores.


Confira a estreia do caderno voltado para os arquitetos.

50 46 18 15

O CEO da Armacell Mansur Haddad fala sobre o crescimento da empresa e o seu destaque na América do Sul. Novidades vêm por aí. Com precioso artigo sobre o tema, o engenheiro Osny do Amaral F°, destaca a importância de um ar mais saudável em ambientes fechados.
“HVAC-R é uma sigla para as palaveras em inglês “heating, ventilation, air conditioning and refrigeration”, referindo-se às quatro funções principais “aquecimento, ventilação, ar condicionado e refrigeração”, intimamente relacionadas à tecnologia destinada ao conforto ambiental interior em edifícios, veículos , processos industriais e ambientes controlado. Essa tecnologia passa a ser referida na forma escrita pelas siglas HVACR, HVAC/R, HVAC-R ou HVAC&R ou correspondentes em português, que são menos empregadas: AVACR, AVAC/R, AVAC-R ou AVAC&R.
REVISTA MUNDO DO AR E DA REFRIGERAÇÃO + EFICIÊNCIA ENERGÉTICA E SUSTENTABILIDADE
PUBLICAÇÃO
Di Rienzo Comunicação & Eventos
JORNALISTA RESPONSÁVEL
Cristiane Di Rienzo cristiane@dirienzocomunicacao.com.br
DIAGRAMAÇÃO
Elisangela C. S. Chagas elicsc@gmail.com
COMERCIAL
Di Rienzo Comunicação & Eventos 55 11 3542-0202

DI RIENZO COMUNICAÇÃO & EVENTOS
Av. Armando Ferrentini, 229 - cj 11
Paraíso - 04303-030
São Paulo SP
ACESSE:

www.mundodoaredarefrigeracao.com.br
Manutenção. O Dicionário Aurélio a define como, “medidas necessárias para a conservação ou a permanência de alguma coisa ou de uma situação”. Já para a ABNT -Associação Brasileira de Normas Técnicas -, a manutenção é conceituada como, “a combinação de todas as ações técnicas e administrativas, incluindo as de supervisão, destinadas a manter ou recolocar um item em um estado no qual possa desempenhar uma função requerida”. Parece simples. E é. Então por que vimos brotar tragédias sem fim, muitas delas advindas justamente da falta de manutenção? Já reparou que quando o desastre é noticiado pela imprensa, uma das causas é sempre a falta dela? No caso dos incêndios,por exemplo, o número de sinistros aumentam ano após ano e, geralmente, têm como pano de fundo a falta de manutenção em sistemas elétricos e em sistemas de ar condicionado. Vide o Museu da Língua Portuguesa, o Museu Nacional, o Ninho do Urubu, o Hospital São Luiz - e voltando no tempo, o emblemático incêndio no Edifício Joelma, em São Paulo, em que pessoasante o seu justo desespero, se jogavam do alto da construção como a única possível solução para lhes resguardar a vida. Estes são apenas um décimo dos casos. Virou nossa reportagem de Capa desta edição: incêndios causados pela falta de um olhar mais cuidadoso com a conservação de produtos, serviços e locais que estão em nosso dia a dia. Vale a pena a leitura. Outro chamado, que vem decorrente da falta de manutenção é a Qualidade do Ar em ambientes internos que respiramos. Sério: o ar tem qualidade e esta é importante para a nossa saúde. Como não se vê, não se sabe em que medida ele está saudável. Acredita? Por isso, convidamos o vice-presidente do Plano Nacional de Qualidade do Ar Interior – PNQAI e diretor do CEAJ – Centro de Engenharia e Arquitetura de Joinville, o engenheiro Osny Amaral Filho, que elucida a questão de forma primorosa sobre o tema.
Por outro lado, em alguns casos não basta manter tem que renovar e é por isso que estreamos o Suplemento Conforto & Arquitetura que, a partir desta edição trará temas sobre o bem-estar interior, incluindo o conforto térmico. Ainda: acompanhe a trajetória centenária da Mayekawa pelo mundo e as mais de quatro décadas da Fujitsu pelo Brasil.
Quer mais?
Vire a página e boa leitura!


Venda de eletrodomésticos cresce 36% no primeiro trimestre. Resultado foi puxado pela demanda por Ar-Condicionado e Ventiladores
m linha com a melhora nos indicadores macroeconômicos, o setor de eletroeletrônicos registrou alta de 36% nas vendas da indústria para o varejo nos 3 primeiros meses de 2024. Trata-se do melhor resultado em um primeiro trimestre nos últimos 5 anos, de acordo com Associação Nacional dos Fabricantes de Produtos Eletroeletrônicos, a Eletros.Foram comercializados 25.548.013 milhões de unidades de eletrodomésticos no País ante a 18.752.554 milhões vendidas no mesmo período do ano passado.
“Este salto nas vendas é importante e muito motivador, pois pode indicar uma recuperação importante da economia caso essa performance positiva se mantenha nos próximos meses”, afirma o presidente executivo da Eletros, Jorge Nascimento. Ainda segundo a Eletros, o bom desempenho do primeiro trimestre significa mais uma etapa de recuperação das perdas registradas pelo setor nos últimos anos e que trouxe algumas sequelas importantes para as indústrias instaladas no Brasil.
“Essa retomada estimula nossas empresas a investirem e ampliar a oferta de produtos cada vez mais inovadores e sustentáveis para os consumidores brasileiros“, pontua Nascimento.
O crescimento expressivo nas vendas do setor foi puxado pela alta demanda de Ar-Condicionado e Ventiladores, impulsionada pelas recentes ondas de calor. Não por acaso os setoriais que mais cresceram foram o de Ar-Condicionado, com resultado positivo de 82%, e

eletroportáteis, que cresceram 43%.
As vendas de Linha Marrom, que tem os televisores como principal produto, também apresentaram bom resultado com crescimento de 17%, seguido do setorial de Linha Branca, que inclui geladeiras, fogões e máquinas de lavar, com desempenho positivo de 11%.
“É importante que haja continuidade na redução da taxa de juros, manutenção do controle inflacionária, a garantia de acesso a insumos mais competitivos, além do avanço nas principais pautas da agenda legislativa, em especial a regulamentação da Reforma Tributária “, pontua Nascimento.
A Eletros defende, ainda, políticas públicas de incentivo à aquisição de eletroeletrônicos mais eficientes e sustentáveis por parte da população.
“A aquisição de eletroeletrônicos mais eficientes é fundamental para o sucesso das ações de descarbonização e políticas públicas de redução do consumo de água, energia e ainda traz economia para as famílias brasileiras. Além disso, fortalece ainda mais uma indústria nacional inovadora e com grande capacidade de geração de empregos e riquezas para o País “, destaca.
Ar-Condicionado cresceu 82% Segundo maior polo produtor de ar-condicionado do mundo, o Brasil assistiu um crescimento surpreendente na demanda por estes produtos no primeiro trimestre de 2024 por conta das fortes ondas de calor registradas no país. De acordo com a Eletros, o crescimento foi de 82% nas vendas com a comercialização de 1.505.483 unidades con-
tra 825.134 registrada nos 3 primeiros meses de 2023.
Linha Branca cresceu 11%
A redução gradual na taxa de juros também influenciou o resultado das vendas no setorial de Linha Branca, que inclui produtos como geladeiras, máquinas de lavar roupa, fogões, entre outros produtos fundamentais para a manutenção da rotina doméstica e que estão presentes na vida de todos os brasileiros. Com crescimento 11%, foram comercializadas neste ano 3.456.438 ante a 3.109.255 milhões de unidades no primeiro trimestre de 2023.
Linha Marrom cresceu 17%
As vendas da Linha Marrom, cujo principal produto são os televisores, cresceram 17% no primeiro trimestre em comparação com o mesmo período do ano passado. Foram comercializadas 2.926.399 contra 2.504.594 no ano passado. Fatores como a queda nos juros, que por sua vez possibilitam melhores condições na tomada de crédito para aquisição de produtos de maior valor, influenciaram no resultado.
Portáteis cresceram 43%
As vendas de eletroportáteis cresceram 43% no primeiro trimestre de 2024 em relação ao mesmo período do ano passado. Foram comercializadas 17.659.693 milhões de unidades contra 12.313.571 nos 3 primeiros meses de 2023. As fortes ondas de calor registradas recentemente também impactaram os indicadores de desempenho dos eletroportáteis, tendo em vista que a demanda por ventiladores influenciou estes números de forma significativa.




Daikin inaugura CT em Salvador (BA) como parte das comemorações de seu centenário!
alvador (BA) ganhou mais um centro de treinamento para profissionais de refrigeração. Trata-se do CT Daikin, inaugurado no último 24 de abril. Localizado no bairro da Pituba, o espaço fornecerá 55 cursos gratuitos ao ano, relacionados à instalação de ar-condicionado e manutenção preventiva dos equipamentos. Essa é a terceira unidade brasi-
leira do grupo Daikin, empresa japonesa especializada em ar-condicionado – as outras duas estão localizadas em São Paulo e no Rio de Janeiro. A estrutura tem 800m2 e conta com dois espaços: um showroom para apresentação de equipamentos e soluções destinado ao consumidor final e o centro de treinamento, “primeiro do tipo no Nordeste”,

divulga a empresa. Em Fortaleza (CE) já existe um espaço que oferta cursos e climatização da empresa, no entanto, funciona por meio da parceria entre a Daikin e o Senai, este responsável pelo fornecimento de cursos particulares. “A ideia é concentrar os nossos esforços aqui [em Salvador] porque vemos muito potencial na cidade, tanto para a demanda de treinamento quanto para o consumo de equipamentos”, afirma o gerente sênior de Marketing, Nilson Murayama. A unidade soteropolitana é diferente do centro de treinamento cearense justamente pela forma como os cursos são ofertados. Em Salvador, o treinamento será ofertado gratuitamente por equipes da Daikin, na Rua Rio Grande do Sul, onde fica o CT da marca. Anualmente, 900 vagas serão disponibilizadas para a comunidade soteropolitana. Além de cursos de instalação e manutenção de ar-condicionado, estarão disponíveis, também, treinamentos de automação, manuseio de equipamentos de alto padrão e instalação de tubulação. A carga horária das turmas varia entre um dia de treinamento a uma semana. As primeiras turmas iniciaram no dia 6 de maio, com o curso Split, com duração de 2 dias. Para se matricular, o interessado deve acessar o site oficial da empresa japonesa. É necessário ter mais de 18 anos e, para matrícula em cursos específicos, o aluno precisa ser alfabetizado e ter experiência com refrigeração. O departamento de Centro de Treinamento da Daikin possui 7 treinadores. A seleção da equipe foi feita a partir da avaliação de participação de cada mentor no mercado e do envolvimento com institutos educacionais, como universidades e Serviço Nacional de Aprendizagem Industrial (Senai). O treinador fixo da unidade de Salvador é um ex-aluno da Universidade Federal da Bahia (UFBA), Gabriel Batista, que possui experiência e qualificação em campo, relacionadas à refrigeração comercial e residencial.



Desenvolvidos para atender normas específicas, os EQUIPAMENTOS MAYEKAWA PARA ÓLEO & GÁS são mais do que EFICIENTES, promovem a QUALIDADE do processoe a INTEGRIDADE do operador.
Mayekawa do Brasil finalizou a entrega da solução desenvolvida especialmente para a Refinaria de Paulínia, a Replan, a maior do País em capacidade de processamento de petróleo: 69 mil m³/ dia, o equivalente a 434 mil barris. Para se ter ideia, sua produção corresponde a aproximadamente 20% de todo o refino de petróleo no Brasil, processando quase a sua totalidade de petróleo nacional, grande parte oriunda da Bacia de Santos (pré-sal). Segundo o supervisor comercial da Mayekawa do Brasil, Flávio Mota, a solução entregue consiste em dois skids de compressores de hidrogênio, denominados Gás de Carga e Gás Combustível. “Estes equipamentos são projetados para operar na unidade de Hidrotratamento (HDT) da Replan, contribuindo para o processamento de hidrogênio na refinaria”, informa. Os equipamentos que compõem os skids, em questão, são um compressor de gás de carga (Feed Gas Compressor), com capacidade máxima de 5881kg/h (2043m3/h) @ 22,47kgf/cm2a; e um compressor de gás combustível (Fuel Gas Compressor) com capacidade máxima de 5177kg/h
(4268m3/h) @ 6,57kgf/cm2a. Mota diz que os equipamentos irão operar na unidade de Hidrotratamento (HDT) da Replan, “um setor crítico para o processamento de hidrogênio na refinaria”.
• Desafio Vencido - Todo o desenvolvimento da solução Replan teve duração de 14 meses, incluindo as etapas de projeto, suprimentos, construção e testes de fábrica. “O maior desafio foi a complexidade do sistema e a natureza do gás (hidrogênio) que irá operar. Este
desafio envolveu considerações especiais de segurança e eficiência, dada a alta reatividade e as propriedades do hidrogênio”, revela Luís Fernando Ferreira, engenheiro e gestor responsável pelo projeto Replan. Entre os diferenciais deste projeto, ele destaca a adequação às normas específicas da Petrobras e do API, bem como a customização para o tratamento de hidrogênio na refinaria. “A engenharia e a construção desses equipamentos foram feitas para atender às exigências específicas do processo de hidrotratamento”, garante Ferreira. E mais: “Eles foram projetados para alta eficiência e segurança no tratamento de hidrogênio dentro da Replan”, complementa. Com o desafio vencido, espera-se que os equipamentos comecem a operar no segundo semestre de 2024. Outro destaque para o desenvolvimento deste sistema, na opinião do engenheiro, foram a experiência e o conhecimento técnico da equipe, fundamentais para o ótimo andamento do projeto, especialmente considerando a natureza desafiadora do trabalho com hidrogênio e a complexidade do sistema de compressores. “Nossa equipe de trabalho contou com cerca de 30 pessoas, abrangendo diferentes áreas como projeto, suprimentos, construção, controle de qualidade e testes de fábrica.”, finaliza Luís Fernando Ferreira. A Refinaria de Paulínia também está interligada aos Terminais das Distribuidoras do Pool Paulínia, Terminal da Petrobras Distribuidora e Base da Liquigás para GLP.






TCL reuniu uma galera importante para apresentar o seu line-up 2024. Realizada na Casa Giardini, em Santo Amaro, (SP), o evento contou com a presença de profissionais de varejo, de revendas, instaladores, parceiros, influenciadores, imprensa entre outros. Dividido em dois períodos, o da manhã, quando recebeu o grupo vindo de países Latam; e o período da tarde, em que recepcionou os convidados do Brasil. Iniciando o evento, a gerente de Comunicação e Marketing na SEMP TCL, Camila Nagamine, deu as boas-vindas aos presentes, chamando ao palco o Quarteto de Cordas da Osesp (Orquestra Sinfônica do Estado de São Paulo), que se apresentou lindamente. Em seguida anunciou a parceria de um ano com o jornalista e apresentador Tiago Leifert, que assume o papel de embaixador da TCL no Brasil. Com seu carisma habitual, Liefert que é expert em territórios estratégicos para a marca – como tecnologia, games e futebol
– será o responsável por criar uma série de conteúdos em redes sociais e lives, além de participar de eventos da TCL. Abrangendo todo o portfólio da marca, a parceria entre TCL e Tiago inclui os portfólios de condicionadores de ar, linha branca e soundbars, além de, claro, os lançamentos de TVs.
LINHA BRANCA - Neste quesito a TCL anunciou a chegada do seu primeiro produto da categoria de linha branca, a geladeira MultiDoor TCL C516CDN(1), marcando a expansão do portfólio da marca e a entrada no segmento. Com capacidade total de 516 litros, o modelo possui tecnologia Twin Eco Inverter e maior economia de energia atingindo classificação A+++ no Inmetro, a mais elevada para a categoria. Além disso, possui Espaço Flex, Metal Cooling, gavetas Multi-Zone, baixo nível de ruído, fluxo de ar inteligente e painel touch, além de contar com garantia de 10 anos no compressor e um ano no produto. Já a geladeira MultiDoor TCL C589CDN1, tem ca-


pacidade de 589 litros. Side by Side TCL C516SBIMN1 - Com capacidade total de 516 litros e disponível na cor inox, a geladeira Side by Side TCL C516SBIM.
Na Linha de Ar Condicionado, a TCL trouxe o Multi Split Inverter - Com a condensadora disponível nas capacidades de 18.000, 27.000 e 36.000 BTU/h, e a evaporadora de 9.000, 12.000, 18.000 e 24.000 BTU/h, o modelo conta com o modo ECO, sistema 100% DC Inverter, conexão Wi-Fi e controle por aplicativo; Split Cassete Inverter - O modelo marca a expansão do portfólio da TCL para a linha comercial leve, tem produção nacional na fábrica da TCL em Manaus (AM) e está disponível nas capacidades de 36.000 BTU/h e 55.000 BTU/h; e o TCL FreshIN 2.0 Inverter - Com exclusivo sistema de renovação de ar, capaz de renovar as taxas de oxigênio com uma vazão de até 60m3/h e manter um controle da umidade do ambiente interno, o modelo permite a qualidade do ar interno em níveis ótimos.
2024 começou com uma nova estrutura administrativa, sediada no Brasil, criada para contribuir com uma melhor gestão e crescimento da América Latina, contando com um novo CEO, o Eason Cai. Essa mudança visa impulsionar não apenas o crescimento nacional em todas as categorias, mas, também, garantir mais integração e autonomia regional – uma vez que, o executivo passa a liderar o mercado brasileiro e mantém sua posição como General Manager da TCL Latin America Business Group (LABG). “Os investimentos da TCL seguem em expansão em todo o mundo e, pela segunda vez, fomos reconhecidos como a 2ª maior marca global de TV, segundo a Omdia. Na América Latina e no Brasil, nosso objetivo é seguir fortalecendo nossa atuação no mercado e impulsionar o crescimento dos nossos negócios de forma estratégica”, comentou Cai. “Meu propósito é dar andamento ao excelente trabalho que já vinha sendo feito na região, concretizando nossa entrada na categoria de linha branca por meio da chegada dos primeiros produtos às lojas, além de liderar a expansão da linha comercial leve de condicionadores de ar”. A marca, que já tem um longo histórico com o universo do futebol, continua investindo nessa estratégia para se aproximar dos consumidores brasileiros, por meio de patrocínio aos árbitros e seleções masculina, feminina e sub-20 da Confederação Brasileira de Futebol (CBF),
além da CONMEBOL Libertadores até 2026. Também, foi na Coletiva de Imprensa que o diretor de marketing da LABG TCL Semp, Dale Chen, explicou que o investimento em patrocínios esportivos é uma estratégia da marca por todo o mundo, “acreditamos que o esporte integra as pessoas e sim, é uma estratégia global investir no esporte, independente de qual produto seja: refrigerador, TV, celular, ar-condicionado ou qualquer outro. Focamos no esporte como sendo o elemento principal de comunicação com a marca”. Além disso, a TCL vem firmando parcerias com grandes nomes como o Tiago Leifert. “Eu e TCL sentimos a mesma paixão por tecnologia, games e futebol. Estou empolgado com todas as histórias que vamos contar pelos próximos meses. A TCL estará praticamente o tempo todo comigo: teremos conteúdo no meu canal de games, no meu canal de futebol e também no dia a dia através de registros no Instagram”, afirma Leifert. Diante deste desta nova configuração para 2024, o CEO da fabricante diz que este é mais um grande passo em seu posicionamento como marca líder no mercado local, a parceria com Tiago se soma às demais iniciativas da TCL, tanto de marketing, como de estratégia de negócios. “A construção e solidificação do nosso relacionamento com consumidores brasileiros passa, também, por nossos contínuos esforços para a campanha global #TCLGreen, que integra o conceito ESG em todos os aspectos do negócio da empresa, desde a construção de fábricas e entre-
ga de produtos eco-friendly, até a otimização de sua cadeia industrial”, finaliza Cai. No evento de lançamento do line-up 2024, a empresa expôs, além dos produtos que chegarão ao Brasil, itens do seu portfólio global e novidades direcionadas ao mercado da América Latina, gerando ainda mais interesse sobre a marca e adiantando tendências que podem chegar ao mercado local no futuro. O alinhamento entre calendários de lançamento global e local é possível graças às duas fábricas que a empresa possui em Manaus - de televisores e condicionadores de ar, além do Centro de Distribuição em Cajamar. E não é apenas em TVs que a empresa está focada: o plano de expansão para as demais categorias também passa por adaptações do seu negócio no Brasil e na América Latina.

[1] Fonte: GFK [2] Fonte: Omdia
Veja mais na SEÇÃO Vitrine, do Suplemento Conforto & Arquitetura, nesta edição e, também, no Portal Mundo do Ar e da Refrigeração.

Philco está com as inscrições abertas para workshops presenciais e gratuitos do programa “Seja um Instalador Philco”, que tem por objetivo a capacitação e o treinamento de instaladores de condicionadores de ar. Na grade do Programa, que teve início em abril, são abordados os princípios básicos de refrigeração, os processos envolvidos em uma instalação, a ligação elétrica entre unidades, além de outros tópicos relevantes para quem deseja se diferenciar nesta área.
Realizados em diversas capitais do País, os treinamentos são ministrados pelo instrutor técnico, Antônio Luiz Guesser, que realiza cursos pelo Brasil e em outros países do Mercosul. Segundo o instrutor responsável pelo Programa, essa expansão dos treinamentos que a empresa está oferecendo aos técnicos em refrigeração é de suma importância para os profissionais porque cria mais um diferencial a este profissional. “Estamos juntos com os instaladores, trazendo os benefícios dos nossos produtos e auxiliando com a parte da instala-
ção, fazendo com que os procedimentos do próprio fabricante sejam seguidos. No fim, é bom para a empresa, para o instalador e para o cliente”, afirmou Guesser.
Para participar é necessário inscrever-se pelo link cursos.philco. com.br/workshops. Gratuitamente. Os workshops presenciais do programa “Seja um Instalador Philco” possuem limite de 100 vagas, já os workshops online não possuem limite de público. As capacitações que vão acontecer remotamente terão temas específicos com transmissão para todo o País nos dias 27 de junho, 21 de agosto e 19 de setembro. O período de inscrições do treinamento online já está disponível no site do curso. Durante a realização, os participantes vão receber certificados dos treinamentos, kit de boas-vindas e participarão de sorteios.
PROGRAMA DE RELACIONAMENTOOs profissionais participantes dos workshops do programa “Seja um Instalador Philco” também podem participar do programa de relacionamento, que foi pensado para oferecer aos refrigeristas um novo canal de atualização, estudos e relacionamento. As vantagens vão desde o acesso a um suporte para instaladores no WhatsApp até um conhecimento amplo e significativo sobre a linha de ar-condicionado Philco, com certificados que garantem uma segurança ainda maior aos clientes.
Philco realiza workshop gratuito para a capacitação de instaladores de Ar-Condicionado
TREINAMENTOS VÃO ACONTECER PRESENCIALMENTE EM TODAS AS REGIÕES DO BRASIL E TERÃO TAMBÉM ENCONTROS ONLINE.
O Programa de Relacionamento é composto por quatro níveis definidos: Bronze, Prata, Ouro e Diamante, sendo que cada área oferece novos benefícios e acesso a cursos diferenciados, à medida que o profissional avança no Programa. Outra característica é que a partir do plano Prata, o refrigerista terá acesso à cupons de descontos para a compra de qualquer produto no site da Philco, tanto para uso próprio, quanto para disponibilizar aos seus clientes. E não é só: todas as categorias do Programa podem ser acessadas a partir do Portal www. cursos.philco.com.br, que traz vídeos de treinamentos, cartilhas, catálogo e páginas de produtos, novidades e lançamentos. Para participar é fácil, basta fazer o cadastro e começar a participar dos treinamentos.

No Brasil há quase cem anos, desde 1934, a Philco é hoje uma das marcas mais presentes na vida do consumidor brasileiro, reconhecida pela alta qualidade dos seus produtos. Seu portfólio é composto por um mix de produtos com mais de 600 itens, incluindo linhas de áudio e vídeo, casa, climatização, cozinha, cuidados pessoais e linha branca composta por refrigeradores, cooktops, purificador de água, adegas, entre outros. Se tratando de linha branca, a Philco também se destaca quando o assunto é ar-condicionado, com uma linha completa que vai desde 9 mil btus até piso-teto e cassete com capacidade de refrigeração de até 60 mil btus. Além de ter disponível também o ar portátil.


o último 14 de maio, a Escola Senai “Oscar Rodrigues Alves”, localizada no histórico bairro do Ipiranga, capital paulista; e dedicada exclusivamente ao setor de HVACR, recebeu a visita do gerente-geral da Midea Building Technologies (MBT), Henry Cheng.
Em visita pela primeira vez ao Brasil e a América do Sul, Cheng separou um tempo na dedicada agenda para conhecer uma das escolas do Sistema Senai, excelência em ensino técnico, que, por sua vez aproveitou a oportunidade para comemorar o quinquênio da parceria com a Midea Carrier, empresa global e fabricante entre outros, de sistemas de ar condicionado e holding que integra a MTB, uma divisão do Grupo Midea, que concentra negócios em produtos, serviços e soluções voltadas para edifícios inteligentes, incluindo fontes de energia, elevadores, sistemas de controle e aquecimento, ventilação e ar-condicionado.
A celebração deu-se com a visita de Cheng e sua comitiva, que além de conhecerem o laboratório de equipamentos de ar-condicionado - dedicado à capacitação dos alunos -, foi recebido pelo diretor da Escola Senai “Oscar Rodrigues Alves”, Eduardo Macedo Ferraz e Souza e sua equipe, que juntos apresentaram as dependências da unidade. “É de grande importância recebermos a visita de Mr. Cheng, uma vez que
a sua presença mostra a proximidade da Escola Senai com a indústria, especialmente com a Midea Carrier, cuja grade de desenvolvimento de ensino vai desde a aprendizagem industrial até a capacitação com ensino técnico, chegando ao nível de pós-graduação, além dos cursos de curta duração”, pontua o professor.
Sobre a sua visita ao Brasil, Henry Cheng conta que a sua divisão é a responsável pelo desenvolvimento da Linha VRF (Fluxo de Refrigerante Variável, na tradução do inglês), produtos com grande potencial de crescimento no Brasil e que, entre outros compromissos, veio conhecer mais de perto o mercado brasileiro. No tangente a parceria entre a empresa e a Escola Senai, que data dos anos 2000, primeiro com a Carrier e, posteriormente, com a Midea Carrier, a partir de
2018, Cheng diz que na visão da Midea Carrier, “nós como fabricantes, temos de prover a todos os instaladores, a capacitação junto aos nossos produtos e a formação técnica a todos os profissionais da área, pois para nós é muito importante que todos os alunos conheçam os nossos equipamentos e estejam familiarizados com a nossa tecnologia”, declara Cheng. Compondo o grupo da fabricante em visita ao Senai, o gerente de pós-venda, Carlos Alberto Foltran Eleutério, informa ainda que a comparticipação entre a marca e a instituição de ensino se estende por outras unidades; “estamos presentes em cinco unidades das Escolas Senai e a previsão para este ano é iniciar a expansão para mais outras sete unidades em outras capitais. “A Midea Carrier tem realizado alguns trabalhos de parceira com o Senai instalando equipamentos do tipo VRF

Com a visita do gerente-geral da fabricante global à instituição, parceria é celebrada.
em várias cidades do Brasil, com o objetivo de auxiliar a Escola na capacitação dos profissionais do curso de refrigeração. Essa visita celebra os cinco anos de parceria entre Midea Carrier e Senai, que trabalham juntos para o desenvolvimento da indústria de climatização e refrigeração no País”, diz.
Ao final da visita, um momento de solenidade em que Henry Cheng consolida a parceria entregando ao professor Eduardo a placa comemorativa pelos cinco anos de trabalhos conjuntos, que agora está fixada na ala dos equipamentos Midea Carrier. “Para o desenvolvimento do nosso laboratório, a empresa forneceu grande parte dos equipamentos Midea Carrier – a outra parte é fornecida pelo Senai -, isso contribui para o desenvolvimento tecnológico da indústria, do setor e assegura o investimento da Midea Carrier na educação profissional no Brasil, já que a empresa possui um portfólio que vai desde o mini split até o sistema de água gelada (Chiller), dando oportunidade para o aluno se desenvolver em vários componentes curriculares, finaliza Eduardo Macedo Ferraz e Souza.







MERCADO

TRABALHANDO
ININTERRUPTAMENTE
DESDE 1924,
TORNOU-SE UM
CONSOLIDADO GRUPO
GLOBAL PROVENDO
EQUIPAMENTOS E SOLUÇÕES COM
TECNOLOGIA DE PONTA PARA O SETOR DO FRIO.


anos






Desenvolvendo tecnologias para o progresso industrial.
Grupo Mayekawa está comemorando 100 anos de atividades ininterruptas no setor do frio. Com dez fábricas ao redor do mundo, 100 escritórios e mais de 5 mil colaboradores diretos, o Grupo Mayekawa foi fundado em 1924, em Tóquio, Japão, por Kisaku Maekawa (sem o y mesmo), que iniciou o seu negócio com uma pequena fábrica de gelo batizada de Mayekawa & Co. O acréscimo do y tem vários significados, um deles “de frente para o rio” vai ao encontro coincidentemente à sua localização às margens do Rio Yamazaki, na capital japonesa.
Para celebrar o seu centenário, o Grupo Mayekawa desenvolveu uma comunicação especial, através de sua logomarca, que marca bem esta data: “A logomarca do centenário será usada por todas as filiais do Grupo durante todo este 2024”, anuncia a coordenadora de Marketing Latam, Caroline Rosa, que comunica algumas outras ações para este ano: “Cada filial desenvolverá a comemoração dos cem anos de acordo com o seu mercado”, diz. “Para chegarmos a cem anos tivemos que ter muito comprometimento com a sociedade e com os seus clientes, por isso, ao longo desse ano teremos alguns lançamentos de equipamentos e também a chegada de novas tecnologias”, antecipa Caroline.
Desde o início, suas atividades seguiram num crescente, com alguns progressos e ino-
vações. Porém, um dos primeiros marcos da companhia data de 1958, quando a Mayekawa já uma fabricante de câmaras frias passou ao patamar de indústria, produzindo sua própria linha de compressores do tipo alternativo. Três anos depois, em 1961 nasce a marca Mycom, nome dado à uma linha de compressores, cujo sucesso foi tamanho, que até hoje a empresa também é reconhecida por este nome. Aliás, aquele também foi o ano que marcou o reconhecimento ao Grupo Mayekawa, por outros países, principalmente por conta da entrega de 156 unidades de compressores de refrigeração para uma instalação frigorífica na ex-URSS (União das Repúblicas Socialistas Soviéticas). Para se ter uma ideia, naquela época, a produção anual da Mayekawa era de 50 compressores, com isto em quase um ano a empresa mais que triplicou sua quantidade produtiva. Marcando, assim, um grande salto de crescimento para a empresa no horizonte global. Em 1963, a Mayekawa apresenta ao mundo o primeiro sistema de resfriamento de recirculação de bomba de amônia líquida, instalado no Japão para armazenamento refrigerado de 7 mil toneladas, o que foi considerado um feito há época.
Sempre em expansão, a Mayekawa segue inovando propondo ao mercado do frio novas tecnologias e soluções, levando a companhia a abrir a sua primeira filial fora do Japão, no ano seguinte: a Mayekawa México.
Em 1968, a companhia aportou no Brasil, onde se estabeleceu, de início, no centro da cidade de São Paulo, na Rua Maria Paula. A subsidiária brasileira é tida hoje como uma das mais importantes do Grupo Mayekawa na América Latina. Isso porque o Japão logo entendeu que o País se apresentava de um mercado abrangente e próspero, tanto que já em 1971 foi importado do Japão a primeira unidade Chiller do mercado brasileiro, com compressor parafuso. Anos mais tarde, em 1996 - a multinacional japonesa realiza os primeiros projetos no mercado de cerveja e bebidas, com sistema indireto NH3 / Solução. Até aquele momento, só havia sistema direto de amônia. Na década da Sustentabilidade, iniciada pela realização da Eco 92, no Rio de Janeiro, o Grupo Mayekawa cria o sistema chamado “Natural Five”, em que são usados cinco fluídos refrigerantes naturais: amônia, dióxido de carbono, água, hidrocarbonetos e ar. Eles são aplicados até hoje em sistemas de aquecimento, secagem, abastecimento de água quente, ar-condicionado, refrigeração e congelamento.
Futuro - 100 anos. Um século. Quantos acontecimentos o mundo viveu: guerras mundiais, progresso nos transportes, revoluções industriais, descobertas científicas, avanços tecnológicos, transformações culturais, aumento substancial da expectativa de vida de sua população entre tantos outros inúmeros cenários. E a Mayekawa foi avançando também: se transformando, transpondo barreiras e ofertando ao mundo equipamentos e tecnologias que fazem a diferença na conservação nas áreas de alimentos, bebidas, saúde, petroquímica, de pesca; entre tantas outras. O nosso compromisso é com a qualidade e a tecno-
logia, no sentido da inovação a fim de desenvolver soluções que contribuam significativamente para a sociedade. Este é o DNA do Grupo Mayekawa, que se perpetua através de gerações, pensando sempre, num futuro melhor para o mundo.
Presente em cinco continentes, o Grupo Mayekawa conseguiu destaque mundial ao fabricar e participar de grandes projetos de engenharia, tais como:
• Petróleo & Gás: No Brasil, o segmento da química da Mayekawa vendeu seu primeiro projeto, uma URV (unidade recuperadora de vapor), para a plataforma petrolífera Pampo, que até aquele momento, em 1999, era administrada pela Petrobras (Petróleo Brasileiro S.A). A venda foi um grande marco para as relações entre as duas empresas.
• Refrigeração e aquecimento residencial: Em 2023 a Mayekawa Europa forneceu o sistema de água quente através da sua solução de bombas de calor para cerca de 8 mil residências na cidade de Svendborg, Dinamarca.
• Navio de Pesca: Uma união de mais de 30 anos é descrita na relação entre a Mayekawa e o navio de pesca Dutch Harbor, ancorado na região do Alasca, Estados Unidos. A Mayekawa EUA realiza manutenção nos cinco compressores N62B há mais de 30 anos. Construído em 1975, o Dutch Harbor trabalha há mais de 40 anos em sua plena capacidade com os compressores da linha Mycom.
• Centro de Distribuição: A Linha Newton foi a escolhida pelo presidente da empresa ADIB Food, Budi Mulyono para estabelecer e expandir sua cadeia de frio e garantir abastecimento alimentar estável aos mais de 240 milhões de habitantes da Indonésia, - naquela época o país enfrentava uma grave escassez de carne
fresca, peixe e vegetais, devido a problemas na logística refrigerado do país.
CO2 Brine: O Grupo Mayekawa se dedicou a desenvolver sistemas de refrigeração indireta que utilizam CO2 Brine para o resfriamento ou congelamento do produto ou para climatização. Neste caso, a carga de amônia é reduzida quando se usa CO2 como fluido refrigerante secundário (Brine), otimizando a eficiência energética e diminuindo o nível de toxicidade, aumentando, assim, a segurança operacional do sistema de refrigeração. Além do Brasil, a multinacional japonesa já aplicou o conceito de CO2 Brine em outros países da América Latina, sendo dois projetos no Equador e um na Argentina. Na Ásia, o Grupo Mayekawa também está presente em mais de 500 instalações de refrigeração industrial utilizando o CO2 Brine.
• Bebidas: Outro marco para a história do Grupo foi em 2004, quando a Mayekawa Brasil fez a primeira venda de chillers para a empresa Sorocaba Refrescos, envasadora de uma das principais marcas de bebidas do mundo.
• Alimentos e bebidas: Desde 2006, temos orgulho de colaborar com uma das maiores empresas de alimentos e bebidas da Suíça, fornecendo as nossas soluções de refrigeração e sistemas de aquecimento para todas as suas fábricas no Brasil. Já são milhares de unidades vendidas, um marco histórico para o Grupo Mayekawa e para o setor.

MERCADO


Fujitsu General comemora 44 anos de existência no Brasil com excelência em ar-condicionado!
Empresa reafirma seu compromisso com o meio ambiente por meio de produtos que utilizam refrigerante R-32, considerado o mais sustentável.
Fujitsu General do Brasil, multinacional japonesa, fabricante de ar-condicionado, celebrou em abril, 44 anos de atividades, marcando quatro décadas de inovação e compromisso com a qualidade de sistemas de ar-condicionado.
Desde a sua chegada em São Paulo, a companhia oferece soluções de climatização e produtos destinados a residências, escritórios e espaços comerciais em todo o território brasileiro. “Estar no Brasil há 44 anos é o resultado de um trabalho árduo e de muita dedicação de toda a equipe, bem como da confiança e do apoio contínuo dos clientes e parceiros da Fujitsu General do Brasil”, afirma o CEO da empresa Akihide Sayama.
EMPRESA AMIGA DO MEIO AMBIENTE
A Fujitsu General do Brasil divulga que nesses 44 anos sempre esteve atenta ao mercado
e, por isso, nesta ocasião reafirma o seu compromisso em proporcionar excelência com produtos sustentáveis e de alta qualidade. Com a missão “Vivendo Juntos pelo nosso Futuro”, a empresa vincula a filosofia e os valores da organização às inovações tecnológicas com propósitos de sustentabilidade para oferecer um futuro melhor às próximas gerações. “Trabalhamos com a gestão sustentável, isto quer dizer que todos os nossos produtos desde a concepção até a sua fabricação são pensados em prol da sustentabilidade”, garante Sayama. Ele vai além: “o mercado pede um posicionamento urgente para as empresas com relação as questões ambientais, por isso também utilizamos o fluido refrigerante R-32 que tem zero impacto na camada de ozônio e possui baixo impacto no aquecimento global em comparação a outros refrigerantes”, complementa.
A Fujitsu General foi fundada em 1936, no Japão e faz parte do Grupo Fujitsu, uma das maiores companhias mundiais de engenharia eletrônica. Após 24 anos de mercado (1960), a Fujitsu iniciou a fabricação em série do seu primeiro modelo de ar-condicionado. Desde então, a empresa tem desenvolvido sistemas de refrigeração de ambientes, que contam com reconhecimento mundial por conta da qualidade e design inovador. Vinte anos depois, em 1980, a Fujitsu chegava ao Brasil. “Nestes 44 anos a empresa enfrentou alguns desafios devido as mudanças ocorridas na legislação que o mercado viveu para a comercialização no setor de ar-condicionado. Entretanto tivemos destaques importantes, entre eles o pioneirismo em trazer a tecnologia inverter para o
Brasil, em 2008, favorecendo o mercado de ar-condicionado e consumo. Além disso, no final de 2022 realizamos a apresentação global da marca Airstage, com divulgação de pré-lançamento no Brasil. Em agosto de 2023, realizamos o lançamento para os nossos clientes das Linhas Premium e Essencial e para todo o mercado de HVCA-R com apresentação na Febrava (Feira Internacional de Refrigeração e Ar Condicionado) da marca Airstage, com os novos produtos da Linha Premium e Essencial”, revela a coordenadora de Marketing Brasil, Fernanda Lúcia Bragatto.
Ela informa que “a Linha Essencial tem produção 100% nacional e possui todas as capacidades de High Wall do mercado. Além disso, conta com uma unidade externa leve e compacta favorecendo uma melhor adaptação em ambientes”. Segundo informa, a Linha Essencial apresenta algumas funções exclusivas, “como o modo Ifeel, fazendo
com que o sensor de temperatura embutido no controle remoto detecte a temperatura do ambiente e transmita um sinal de volta para a unidade, proporcionando o máximo de conforto”.
Sobre a Linha Premium, Fernanda discorre que o modelo conta com uma gama de equipamentos de ar-condicionado dos modelos Split High Wall, Teto e Cassete com fluido R-32 e tecnologia inverter. “Saliento, também, que os equipamentos da Linha High Wall contam com IDRS (Índice de Desempenho de Resfriamento Sazonal), até 49% superior a classificação A, do InMetro. Os modelos High Wall de capacidade de 9 e 12 mil BTU/H possuem selo Procel, categoria Ouro por sua eficiência energética ser muito mais elevada que a exigida pelo mercado até 2026”, afirma.
Na opinião da coordenadora de Marketing da Fujitsu General do Brasil, o mercado de HVAC passa por uma fase de transformação significativa, impulsionada por tendências como: design, sustentabilidade, conectividade, eficiência energética e foco na qualidade do ar interior para o bem-estar e conforto de todos. “As empresas que conseguirem se adaptar as mudanças, oferecendo soluções inovadoras e eficientes estarão bem-posicionadas para aprovei-


tar as oportunidades de crescimento neste mercado cada vez mais promissor”, analisa. Sobre o mercado, ela estima que aproximadamente 20% das residências no Brasil contam com equipamentos de ar-condicionado, por isso, “sabemos e reconhecemos o potencial de crescimento deste segmento. A nossa missão e objetivo é aumentarmos o line up da empresa com novos produtos para que possamos acessar novos mercados e clientes”, adianta. Outro ponto interessante também que vale a pena evidenciar é o crescimento do market share da empresa, em parceria com os distribuidores parceiros. “Um dos nossos pontos de destaque também é aumentar a participação da marca em praças antes menos acessadas, como a região Nordeste, que agora passa a contar com equipamentos da Linha Essencial’, antecipa. Para Akihide Sayama, “à medida que olhamos para o futuro, estamos comprometidos em continuar oferecendo soluções inovadoras, que melhoram cada vez mais o conforto e a qualidade de vida das pessoas, ao mesmo tempo em que contribuímos para um ambiente ainda mais sustentável”, finaliza o CEO da Fujitsu General do Brasil.















Principal fator contribuinte para a ocorrência de sinistros, o olhar menos atento para instalações de sistemas de ar condicionado e suas manutenções, contribuem para o aumento de casos de incêndio - sejam eles gerados por curtos-circuitos na parte elétrica, vazamentos de gás, fluidos ou líquidos inflamáveis, descaso destrói patrimônios, sonhos e vidas.
Por Cristiane Di Rienzo e Luciano Guimarães





“TODOS OS FATOS E PERSONAGENS DE GRANDE IMPORTÂNCIA NA HISTÓRIA DO MUNDO OCORREM, POR ASSIM DIZER, DUAS VEZES”.
“A PRIMEIRA VEZ COMO TRAGÉDIA, A SEGUNDA COMO FARSA”.
om, pelo menos no Brasil, na maioria das vezes, a história tem se repetido como uma tragédia anunciada, pelo menos no caso de sinistros de incêndio, conforme comprovaram as diversas ocorrências que marcaram o País ao longo das décadas, a exemplo dos episódios envolvendo o Edifício Joelma, em São Paulo (SP), em 1974; a Boate Kiss, em Santa Maria (RS), em 2013; e o Museu Nacional, no Rio de Janeiro (RJ), em 2018.
A receita também é sucessivamente a mesma – a maioria dos incidentes é gerada por negligência humana, seja de
agentes do poder público, ou das pessoas responsáveis pelo imóvel. Esses personagens geralmente contribuem decisivamente para a ocorrência de sinistros, incluindo a ausência de atendimento a legislações, equipamentos de segurança, treinamentos e de manutenções preditivas de instalações elétricas, além do armazenamento inadequado de materiais inflamáveis.
Outro fator decisivo encontra-se na falta de documentos fundamentais para a operação de estabelecimentos comerciais e habitabilidade de moradias coletivas. Até mesmo
prédios públicos já foram flagrados sem essa papelada, que pode incluir o auto de vistoria emitido pelo Corpo de Bombeiros (AVCB), o alvará de funcionamento de responsabilidade das prefeituras e até planos de emergência e contingência contra incêndios que cada local precisa ter.
Embora cada tragédia impulsione debates sobre a aprovação de legislações mais rigorosas, e muito tenha se avançado nesse sentido desde a década de 1970 para cá, a incidência de incêndios no País continua alta, representando uma séria ameaça à segurança pública,
ao patrimônio histórico e à vida humana.
Levantamento do Instituto Sprinkler Brasil (ISB), organização sem fins lucrativos que difunde o uso de sprinklers nos sistemas de prevenção e combate a incêndios em instalações industriais e comerciais, revelou a ocorrência de 2.222 incêndios estruturais no País em 2023, alta de 8,9% ante o ano anterior. Nesse mesmo período, a entidade contabilizou 49 sinistros em hospitais, representando alta de 16,9% em comparação a 2022.
“Encerramos 2023 com as ocorrências de incêndio ainda em crescimento. Muitas vezes, eles acontecem por problemas na falta de qualidade de equipamento, falta de manutenção, erros de projetos e de instalação e problemas no treinamento de mão de obra”, relata Marcelo Lima, consultor do ISB. “Notamos que há um desinteresse dos proprietários pela proteção contra incêndios, fazendo somente o mínimo necessário para ser aprovado pelos bombeiros”, complementa.
O consultor enfatiza ainda que os incêndios em hospitais são muito graves porque, diferentemente de outros tipos de ocupação, não se pode movimentar os pacientes verticalmente, no máximo transportá-los em um mesmo pavimento.
“Em hospitais sem proteção adequada contra incêndios, isso é impossível. O que vemos toda hora são pacientes sendo trazidos em macas para a rua, como em um cenário de guerra, muitas vezes colocando em risco a vida dos pacientes. Isso não seria necessário se os hospitais tivessem áreas adequadas de resguardo em todos os pavimentos e sistemas de sprinklers para conter o fogo






em uma pequena área”, argumenta Lima.
Recentemente, o ISB passou a fazer parte da International Fire Safety Standards Coalition (Coligação Internacional de Normas de Segurança Contra Incêndios), que reúne 80 organizações com objetivo de pesquisar, desenvolver, divulgar e implementar globalmente os padrões adequados para os setores de construção e imobiliário.
O ano de 2024 já começou movimentado, com um incidente em estabelecimento de saúde. Em 11 de janeiro, por exemplo, um princípio de incêndio no Hospital São Luiz Morumbi, em São Paulo, resultou na transferência de 47 pacientes para outras unidades hospitalares. O episódio ocorreu por volta das 8h40, daquela quinta-feira, devido a uma pane em um equipamento eletrônico.
Infelizmente, uma paciente de 94 anos morreu após sofrer uma parada cardíaca durante o incidente. O fogo e a fumaça afetaram o funcionamento de duas UTIs, que foram evacuadas para a área externa, com parte dos pacientes ainda nos leitos.
Um dos piores incêndios em hospitais do Brasil se deu em 2019, no Hospital e Clínicas São Gonçalo (Badim), no Rio de Janeiro. Um curto-circuito em um gerador no subsolo do imóvel deu início às chamas, que se espalharam rapidamente por diferentes andares. A fumaça densa dificultou a evacuação e onze pessoas acabaram perdendo a vida, mas esse número subiu para 25 nos meses seguintes, por causa de complicações por inalação de fumaça.
Outro grave incidente foi registrado em 27 de outubro de 2020, no Hospital Federal de Bomsucesso, maior hospital da rede pública do estado do Rio


de Janeiro em volume geral de atendimentos mensais. De acordo com o comandante-geral do Corpo de Bombeiros à época, Leandro Monteiro, o local “não estava adequado” e tinha duas notificações e dois autos de infração, “não possuindo certificado de aprovação do Corpo de Bombeiros”. O fogo começou no almoxarifado de um dos prédios, área que ficava no subsolo e armazenava materiais inflamáveis. Dezesseis pessoas morreram.
O Brasil também é pródigo em incêndios em prédios comerciais aparentemente seguros. Duas tragédias separadas por somente cinco anos, mas unidas por suas terríveis semelhanças, marcaram profundamente a história de dois edifí-
cios emblemáticos.
Em 27 de abril de 1976, em Porto Alegre (RS), um incêndio de grandes proporções atingiu o edifício de dez andares onde ficava a Lojas Renner. Uma bituca de cigarro descartada descuidadamente no estoque inflamável de tintas e solventes foi apontada como o gatilho dessa tragédia. Com escadas estreitas e apenas 20 extintores de incêndio disponíveis, o local dificultou o trabalho dos bombeiros e socorristas para salvar as 350 pessoas que estavam na loja. O fogo matou 41 pessoas e feriu outras 60.
Em janeiro de 1981, em pleno sábado de carnaval, o Edifício Grande Avenida, na área central da capital paulista, foi incendiado a partir de uma sobrecarga elétrica. As falhas de segurança, crônicas desde o incidente an-
terior, nos idos de 1959, agravaram o desastre. Duas agências bancárias, escritórios e até a torre da TV Record estavam alojados ali, contribuindo para uma situação potencialmente catastrófica. A escassez de água e a falta de portas corta-fogo na rota de escape exacerbaram a tragédia. Houve 17 mortes e 53 feridos. A maioria dos óbitos ocorreu com trabalhadores da Construtora Figueiredo Ferraz.
As causas de incêndio dividem-se em quatro categorias: elétrica, vazamento de gás, inflamáveis e manuseio na cozinha. Uma das mais respeitadas especialistas no tema no Brasil, a engenheira civil e de segurança do trabalho Ana Paula de Camargo Kinoshita explica que, na questão elétrica, 90% dos casos de sinistros de incêndios originam-se em curtos-circuitos, em função do uso de materiais sem certificação e controle de qualidade e sem aprovação de órgãos como o Inmetro (Instituto Nacional de Metrologia, Qualidade e Tecnologia) e o IPT (Instituto de Pesquisas Tecnológicas).
“Esses materiais requerem atenção porque podem superaquecer, ocasionando derretimento do revestimento plástico do fio, podendo causar o incêndio, o qual vai propagar-se por materiais de fácil com-

A Armstrong pode ajudar a melhorar o desempenho dos sistemas mecânicos e reduzir os custos durante todo o ciclo de vida de um empreendimento.
Economia nos gastos da construção
Redução nos gastos operacionais
100 % de conforto para os ocupantes
50 % de redução nos Custos em reparos e substituições

Para mais informações, visite-nos armstrongfluidtechnology.com ou ligue para – 011 4785 1330
envie um e-mail para: comercialbr@armstrongfluidtechnology.com

bustão, como tecido, plástico, papel e madeira”, detalha a perita judicial e assistente técnica no Tribunal de Justiça de São Paulo (TJSP) e Tribunal Regional do Trabalho (TRT-SP), que recomenda “a manutenção periódica, a troca das fiações e um novo dimensionamento da rede de energia para evitar incêndios, isso em qualquer edificação”, avalia.
No caso de vazamento de gás, já ocorreram sinistros originados de aquecedores de água, existentes na maioria das edificações e condomínios residenciais. “Quando esse problema ocorrer deve-se deixar
todas as janelas e portas abertas, assim os ambientes ficarão bem ventilados. E não ligar as luzes”, emenda Ana Paula, salientando que o fogo também pode ser gerado por produtos inflamáveis indevidamente armazenados e por manuseio em cozinhas.
A preocupação com o histórico problema dos incêndios e acidentes elétricos no Brasil está mobilizando outras entidades especializadas na área, como a Associação Brasileira de Conscientização para os Perigos da Eletricidade (Abracopel). Neste ano, a organização iniciou a atualização de um levantamento de dados, anteriormente feito em 2017, sobre a presente situação das instalações elétricas residenciais. No ano passado, a Abracopel já havia publicado dados sobre a situação das instalações elétricas comerciais. “Nós temos vários problemas no País. A pesquisa residencial já mostrava um cenário triste, caótico, e agora queremos saber se houve melhora ou não. Mas é terrível. E isso também inclui as instalações elétricas em relação aos condicionadores de ar,

que na maioria dos casos é feita de forma inadequada e irresponsável”, avalia o engenheiro eletricista e de segurança do trabalho, Edson Martinho, fundador e diretor-executivo da Associação.
O dirigente explica que os acidentes acontecem de várias formas, mas principalmente por choque elétrico com fios e cabos desencapados ou malconservados, emendas sem tampas, extensões largadas pelo chão ou mesmo desgastadas, além do uso inadequado do “T” de Benjamin. “Deixar de cuidar da instalação elétrica, a torna perigosa, assim como o uso de equipamentos acima do limite das capacidades dos fios e cabos, além da ausência de proteções, como disjuntores ou fusíveis. O aquecimento dos fios acaba principiando um incêndio”, complementa Martinho.
Por outro lado, o setor tem registrado um forte aumento na procura de itens de segurança cada vez mais modernos para prevenir, minimizar ou mesmo combater incêndios. A partir desta realidade, o mercado tem

visto, ao longo do tempo, o desenvolvimento de tecnologias inovadoras capazes de aumentar a segurança nas edificações, ainda que o fator humano seja decisivo para o sucesso de iniciativas anti-incêndio.
Segundo a engenheira Ana Paula Kinoshita, a lista inclui sistemas de detecção e alarmes inteligentes, hidrantes, sprinklers e sistema de nebulização conhecidos como water wist, que usa 90% menos água e extingue o incêndio muito rapidamente, além de bola extintora, que ao ser lançada ao fogo, o apaga imediatamente.
Já no caso do setor de HVACR, a área de ventilação disponibiliza tecnologias que cumprem o papel de auxiliar na prevenção e combate a incêndios. Há ainda as escadas pressurizadas, cuja principal função é impedir que a fumaça oriunda de um sinistro se propague pelo empreendimento, fazendo com que as saídas fiquem aptas e com pressão positiva, para que em momentos de emergência, as pessoas possam sair em segurança.
O engenheiro Carlos Santos Júnior, da Sicflux, empresa fabricante, localizada em Araquari (SC), destaca que “primeiramente é importante diferenciar sistemas de prevenção e combate de incêndios e sistemas de controle de incêndios, ou como foi citado ‘propagação de fu-

maça’ ”, avisa. Ele continua: “os processos que evitam que o incêndio evolua se utilizam extintores, “sprinklers” (aspersores ou chuveiros de água) ou mangueiras de água. O objetivo dessa solução é apagar um incêndio em sua fase inicial, crescimento ou completamente evoluído, e é um sistema de proteção de patrimônio. Por outro lado, o controle de calor e fumaça é um sistema de proteção de vidas, que garante que usuários de um edifício consigam realizar a rota de fuga sem que sejam contaminados pelo monóxido de carbono ou sofram com queimaduras. “Utilizando o exemplo da Boate Kiss, um sistema de prevenção ou combate de incêndio iria evitar que o fogo se espalhasse pelo material do forro, enquanto o sistema de controle de fumaça iria evitar o acúmulo de fumaça dentro da boate por tempo suficiente até que todas as pessoas escapassem com segurança”, garante.


Os equipamentos para controle de fumaça dependem do tipo de controle que se deseja ter sobre o processo de incêndio e por quanto tempo permanecerá ativo. “Nesse sentido, existem métodos considerados como ventilação de emergência, onde o sistema atua por apenas alguns minutos, em torno de 10 a 15, que seria o intervalo necessário para que pessoas saudáveis e em plenas capacidades de locomoção fujam do edifício a partir do princípio de incêndio. Uma vez que se trata de um pequeno intervalo de tempo, tanto a infraestrutura de dutos quanto ventiladores não necessita ter um tratamento especial,
por isso podem ser aplicados exaustores convencionais que são usualmente aplicados em projetos de conforto, como o o Titan LS (limit load de simples aspiração), Titan CTL (centrífugo tubular limit load), e até mesmo ventiladores axiais com motores no fluxo, no caso o Titan VAL”, explica o engenheiro da Sicflux.
Para casos em que o controle de fumaça deve operar por mais tempo, entre uma e duas horas, conforme legislação vigente em cada estado, todo o sistema deve resistir a esse tempo com exposição de temperatura de 400 oC. Para isso, utiliza-se ventiladores com construção especial, podendo
ser de dois tipos: equipamentos com motores e mancais convencionais montados fora de fluxo, onde não possuem influência da temperatura, “que é o caso do modelo Titan LSF (limit load de simples aspiração para fumaça); ou equipamentos com motores de fabricação específica para operar em uma condição de ar com fumaça e alta temperatura. Para esses casos, pode-se utilizar os modelos Titan Val-Smoke (axial com preparação para fumaça) ou o CTL-Smoke (Centrífugo tubular com preparação para fumaça)”, sugere Carlos.
É importante lembrar que em processos de exaustão deve ser considerado também um sistema de renovação de ar trabalhando em paralelo de forma que seja garantida a reposição de ar. Pode parecer contraintuitivo utilizar um ventilador que traga ar externo para dentro de um ambiente sinistrado com fumaça e imaginar que isso tende a alimentar o incêndio com oxigênio, porém esse processo é determinante para garantir uma exaustão eficiente com direcionamento de fumaça para o ambiente externo da maneira correta, além de prover ar respirável às pessoas em rota de fuga. Caso esse formato de reposição de ar seja aplicado de forma forçada em vez da forma

natural, a Sicflux disponibiliza também gabinetes de ventilação como o SGSD (sirocco de dupla aspiração e acionamento indireto) e GLPF (gabinete limit load plenum fan) que podem operar inclusive com filtragem.
Bem-posicionada neste nicho de mercado, a Projelmec Ventilação Industrial também dispõe da linha 400°C2H, composta por ventiladores do tipo axial (arranjos 4 e 9) e centrífugos (de aspiração simples e dupla). Os equipamentos contam com estrutura reforçada, bem como componentes dimensionados para o funcionamento em altas temperaturas.


“A linha 400°C2H caracteriza-se por operar ininterruptamente, sem redução de capacidade, a uma temperatura de até 400 °C por um período de pelo menos duas horas”, descreve a engenheira mecânica Laura Baldissera, diretora comercial da empresa gaúcha sediada em Sapucaia do Sul.

Segundo ela, embora existam normas e regulamentações claras relacionadas à instalação e manutenção de ventiladores para prevenção e combate a incêndios, a conformidade nem sempre é garantida. “Muitas empresas podem não estar cientes ou mesmo negligenciar essas normas, resultando em instalações inadequadas ou manutenção deficiente”, completa.
Outros pontos de atenção, argumenta Laura, dizem respeito a instalação e a manutenção de ventiladores de prevenção e combate a incêndios, que exigem profissionais trei-

nados e qualificados. “A falta de capacitação e atualização dos técnicos pode levar a falhas na instalação, à manutenção inadequada ou até mesmo a riscos de segurança”, arremata.
Igualmente atuante neste segmento do setor do frio, a Otam Soler & Palau Brasil, de Porto Alegre (RS), tem uma linha completa de equipamentos aptos a operar em caso de sinistros. São ventiladores centrífugos e axiais que atendem às especificações de engenharia exigidas nas regulamentações de equipamentos contra incêndio, que podem chegar ao ventilador ter que operar

por duas horas a 400 oC. Esses ventiladores são usados para o salvamento de vidas, mantendo corredores com ar respirável, possibilitando ou facilitando a fuga dos ocupantes dos edifícios e a entrada dos bombeiros, visto que as mortes em incêndios são normalmente causadas por asfixia e não propriamente pela temperatura. Os equipamento possuem características de projeto e utilizam materiais especiais para resistir à temperatura por um tempo determinado, mantendo sua operação normal, mas acabam por ficar inutilizados após o sinistro. Sistemas de controle de fumaça podem ser utilizados em qualquer ambiente interno construído e que se deseja garantir a rota de fuga dos usuários em caso de incêndio. Devido a uma combinação de fatores como poder de combustão de materiais armazenados, quantidade de pessoas aglomeradas, exigências específicas de legislação e custos envolvidos para viabilizar, o sistema é aplicado principalmente em edifícios residenciais de múltiplos pavimentos (geralmente acima de 10 andares), shoppings, supermercados, agências bancárias, hospitais, além de uma série de aplicações industriais", informa José Fernando Batalha.
Quanto às escadas pressurizadas, ele explica que "elas tem como principal função impedir que a fumaça oriunda de um sinistro, se propague nos empreendimentos, fazendo com que as saídas fiquem aptas e com pressão positiva para que num momento de emergência, as pessoas possam sair, evacuar em segurança".
O Plano de Manutenção, Operação e Controle (PMOC) de Ar-Condicionado é uma medida essencial para garantir
a qualidade do ar interior e a saúde dos ocupantes em ambientes climatizados. O PMOC garante que os sistemas de ar-condicionado funcionem de forma adequada, mantendo a qualidade do ar interno. Isso é crucial para prevenir problemas de saúde decorrentes da má qualidade do ar, como alergias, irritações respiratórias, entre outros.
A partir da Lei nº 13.589/2018, o PMOC passou a ser obrigatório em edifícios de uso público e coletivo com ambientes climatizados artificialmente.
Afinal, um sistema de ar-condicionado sujo ou mal ajustado pode consumir mais energia para operar. Com um PMOC, os sistemas são regularmente verificados e ajustados, resultando em economia de energia e redução nos custos de operação. E, evidentemente, evitar possíveis incidentes envolvendo picos de energia e curtos-circuitos.
“Embora muito se fale sobre a qualidade do ar, a execução de um PMOC vai além, pois também contribui significativamente para a redução dos riscos de incêndios nessas estruturas”, afirma Jéssica Thays Correia, coordenadora de projetos na Leankeep Software. Segundo ela, ao identificar falhas e problemas de forma precoce e realizar manutenções regulares nos sistemas de climatização, consegue-se mitigar os riscos de incêndios. Isso é possível através da promoção da limpeza adequada dos componentes do sistema e da realização de verificações na instalação elétrica, por exemplo.
“Dessa forma, um PMOC bem executado não apenas garante a qualidade do ar interior, mas também oferece uma camada adicional de segurança ao minimizar os riscos de incêndios em estruturas de ar-condicio-

nado, proporcionando ambientes mais seguros e saudáveis para todos os ocupantes”, complementa a gestora.
A construção de um PMOC apresenta desafios significativos, entre os quais estão o levantamento e a identificação dos ativos da edificação, a definição das manutenções preventivas e o subsequente monitoramento de sua execução. “Quanto maior a quantidade e diversidade de ativos, mais complexa se torna essa tarefa”, salienta Jéssica.
Para o engenheiro de Segurança do Trabalho, Alberto Solinas, a prevenção de incêndios está amparada no tripé: equipamentos eficientes, instalação elétrica em dia, e manutenção periódica. “Se uma dessas pontas falhar a probabilidade de sinistros aumenta, pois um equipamento que não é eficiente, não dá conta das necessidades do ambiente, no caso de um sistema e ar condicionado, por exemplo; também, se a parte elétrica não estiver em ordem e devidamente revisada, haverá problemas; e, ainda se essas duas partes estiverem adequadas, mas não houver um comprometimento com a manutenção dos sistemas, será apenas uma questão de tempo para que algum sinistro ocorra”, finaliza Solinas.

Há diversas legislações referentes à prevenção de incêndios que surgiram ao longo dos anos, geralmente após a ocorrência de incidentes marcantes. Entre elas, destacam-se a Lei Complementar nº 14.376/2013 (Lei Kiss), sancionada pelo governo gaúcho, e a Lei Kiss, em âmbito nacional, promulgada pelo governo federal em março de 2017.
Entretanto, a lei gaúcha teve seu rigor diminuído pelos deputados estaduais, primeiro em 2016, quando aprovaram a ampliação do prazo de validade dos Alvarás de Prevenção e Proteção Contra Incêndios (APPCI) e a redução da frequência das inspeções nos estabelecimentos que operam em espaços fechados.
E no dia 27 de dezembro de 2023, o governo do Rio Grande do Sul publicou o Decreto Estadual nº 57.393, adiando o prazo de adequação à LC 14.376/2013 para as edificações e áreas de risco de incêndio existentes se adaptarem ao Plano de Prevenção Contra Incêndios. Enquanto o PPCI deve ser protocolado até 27 de dezembro deste ano, o prazo para obter o APPCI foi prorrogado até 27 de dezembro de 2026.

No entanto, a primeira referência que deve ser consultada em qualquer projeto ou especificação de equipamentos é a diretriz do Corpo de Bombeiros do estado onde se aplica. Denominadas como “Instrução Normativa (Santa Catarina)”, “Instrução Técnica (São Paulo)”, “Normas de Procedimentos Técnicos (Paraná)”, são exemplos de referências estaduais que versam sobre como os sistemas devem ser previstos e operados. Isso demonstra que o Brasil é um País que não possui centralização de normas e praticamente em cada estado há um texto diferente com suas respectivas exigências. Da mesma forma, existem normativas técnicas da ABNT, como a NBR

14880 (sistemas de controle de fumaça por pressurização), NBR 16983 (sistemas de controle de fumaça por exaustão), que também possuem orientações e métodos de cálculo que muitas vezes são referenciadas pelas normas do Corpo de Bombeiros. Dependendo do tipo de aplicação, também existem normas que falam sobre como os ventiladores devem ser construídos, é o caso da NBR 14518, que fala de cozinhas industriais, e até mesmo do projeto da norma 17156, que aborda sistemas de exaustão de churrasqueiras em edifícios de múltiplos pavimentos. Outras legislações também fazem parte da lista que deve ser obedecida. Atualmente, destacam-se as 43 Instruções Técnicas emitidas pelo Corpo de Bombeiros, além das Normas Regulamentadoras 20 e 23, do Ministério do Trabalho. A “NR-20 – Segurança e Saúde no Trabalho com Inflamáveis e Combustíveis” (gases e líquidos) estabelece a obrigatoriedade de Projeto de Instalação; Plano de Inspeção e Manutenção; Análise de Riscos; Plano de Prevenção e Controle de Vazamento, Derramamentos, Incêndios e Explosões e Identificação das Fontes de
Emissão Fugitivas; e Plano de Respostas à Emergência. Esta NR não se aplica às plataformas de petróleo nem às edificações residenciais unifamiliares.
Já a “NR-23 – Proteção Contra Incêndios” disciplina as regras complementares de segurança e saúde no trabalho previstas no art. 200 da CLT. As seis regras dessa legislação são a obrigatoriedade de identificação e classificação dos riscos de incêndio; sistemas de detecção e alarme; extintores e equipamentos de combate a incêndio; rotas de evacuação; treinamento de pessoas; e plano de emergência.
As edificações são classificadas quanto ao risco de incêndio como “risco pequeno”, “risco médio 1”, “risco médio 2” e “risco grande”. E por seis diferentes aspectos que são analisados, para se determinar a classificação das edificações ou áreas de risco – ocupação ou uso; altura; carga de incêndio; área construída; capacidade de lotação; e outros riscos especiais.
Outra norma de destaque é a “ABNT NBR 5410:2004 – Instalações Elétricas de Baixa Tensão”, a qual estabelece as condições a que devem satisfazer as instalações elétricas de baixa tensão, a fim de garantir a segurança de pessoas e ani-
mais, o funcionamento adequado da instalação e a conservação dos bens.
As regras aplicam-se principalmente às instalações elétricas de edificações, qualquer que seja seu uso (residencial, comercial, público, industrial, de serviços, agropecuário, hortigranjeiro etc.), incluindo as pré-fabricadas.
ABNT NBR 5410:2004 aplica-se também às instalações elétricas em áreas descobertas das propriedades, externas às edificações; de reboques de acampamento (trailers), locais de acampamento (campings), marinas e instalações análogas; e de canteiros de obra, feiras, exposições e outras instalações temporárias.
Onde a fiscalização está presente o funcionamento dos sistemas é determinante para liberação de ocupação dos edifícios, as normas são atendidas, porém o problema é mais profundo. Como citado, as exigências não são centralizadas no Brasil e isso gera uma sensação de falta de parâmetro e consenso para afirmar o que é bom ou ruim. Afinal, se uma prática é permitida em São Paulo, mas é proibida em Santa Catarina, ela é considerada boa ou ruim? Fica o questionamento. Além disso, percebe-se que uma parcela razoável de construtoras e empresários tratam os sistemas de controle de incêndio como um custo e um mal necessário que precisa ser executado para que o prédio tenha aprovação de ocupação. Isso implica em pouco zelo considerado na especificação de equipamentos, boas práticas de projeto e instalação, além de, claro, pouca preocupação com a manutenção dos sistemas. Dessa forma, os principais problemas estão na forma que o sistema é cobrado na legislação e, também, na maneira que os clientes e usuários enxergam valor e importância, conclui o engenheiro Carlos Santos Júnior.
A revista é produzida pela Di Rienzo Comunicação & Eventos. A distribuição é gratuita. Para recebê-la basta acessar: www.mundodoaredarefrigeracao.com.br e se cadastrar no campo “NewsLetter”. Pronto! Você receberá as edições impressas e digitais!
















envolvendo o sistema de Ar Condicionado e a parte elétrica
Edifício Andraus. O incêndio no arranha-céus de 32 andares ocorreu em São Paulo, em 24 de fevereiro de 1972, no centro financeiro da cidade. O fogo teve início em um dos andares superiores, devido a um curto-circuito em uma instalação de ar-condicionado. As chamas rapidamente se espalharam por materiais inflamáveis e pela falta de compartimentação adequada. Este trágico evento levou à revisão das normas de segurança contra incêndios no Brasil, resultando em regulamentações mais rigorosas e na implementação de medidas preventivas, como a exigência de sprinklers em novas construções.
Edifício Joelma. Em 1º de fevereiro de 1974, um incêndio de grandes proporções irrompeu no Edifício Joelma, um dos primeiros arranha-céus de São Paulo, então alugado ao Banco Crefisul de Investimentos. O fogo teve início no 12º andar, ocupado por esta instituição, resultado de um curto-circuito no sistema de refrigeração. O vento e a falta de segurança do prédio logo fizeram as chamas se alastrarem.
Museu da Língua Portuguesa. Ocorrido em 21 de dezembro de 2015, o incêndio representou uma tragédia cultural e histórica para o Brasil. Localizado na Estação da Luz, o museu é um espaço dedicado à valorização e promoção do nosso idioma. O fogo teve início após um curto-circuito em um refletor em uma das salas. As chamas consumiram parte da estrutura do museu, causando danos significativos às instalações e às exposições. O local funcionava sem o auto de vistoria do Corpo de Bombeiros e licença de funcionamento da prefeitura. Boate Kiss. Em 27 de janeiro de 2013, um incêndio na casa de shows, localizada em Santa Ma-

ria, Rio Grande do Sul, resultou em uma das maiores tragédias recentes do País. O fogo começou após o uso inadequado de sinalizadores durante a apresentação de uma banda, e a boate estava superlotada e mal preparada para emergências. O caso foi uma grande sequência de erros e omissões dos poderes públicos. Um documento precário emitido pelos bombeiros foi usado como Plano de Prevenção e Combate a Incêndio (PPCI), em 26 de junho de 2009, e o estabelecimento funcionou sem o alvará de localização da prefeitura, só emitido em 2010; na data do incêndio, o alvará estava novamente vencido.1
Edifício Wilton Paes de Almeida. O desabamento do prédio de 24 andares no Largo do Paissandu, no Centro de São Paulo, aconteceu em 1º de maio de 2018. O incêndio começou por volta da 1h30 e se espalhou rapidamente pelo prédio, consumindo vários andares. As chamas foram tão intensas que enfraqueceram a estrutura do edifício, levando ao desabamento por volta das 3h30. Uma das hipóteses levantadas pela investigação foi a possibilidade de um curto-circuito elétrico ter dado início ao fogo, mas as investigações não foram conclusivas.

Museu Nacional. Em 2 de setembro de 2018, um incêndio consumiu o Palácio de São Cristóvão, que abrigava grande parte do acervo do Museu Nacional, localizado no Rio de Janeiro. O fogo destruiu a maior parte das 20 milhões de peças do acervo histórico, científico e cultural da instituição, incluindo artefatos raros e únicos. Em 2020, a Polícia Federal encerrou as investigações sobre a tragédia e afirmou que o incêndio não foi criminoso. As chamas foram iniciadas a partir de um curto-circuito causado pelo su-

peraquecimento em um aparelho de ar-condicionado. Acredita-se que o fato ocorreu por falta de manutenção adequada e de investimentos.
Ninho do Urubu. Em 8 de fevereiro de 2019, às 5 horas, um incêndio devastador ocorreu no centro de treinamento do Flamengo, localizado na zona oeste do Rio de Janeiro. O fogo começou devido a um curto-circuito nas instalações do sistema de ar-condicionado do alojamento, que irregularmente hospedava 26 jovens atletas das categorias de base. O CT operava sem alvará de funcionamento nem licença do Corpo de Bombeiros. O clube foi multado 30 vezes pela prefeitura do Rio e, mesmo assim, continuou operando o centro de treinamento.
Hospital e Clínicas São Gonçalo (Badim). Na noite de 12 de setembro de 2019, um incêndio atingiu a instituição de saúde localizada na Tijuca, Zona Norte do Rio de Janeiro. O fogo teve origem em um curto-circuito em um gerador no subsolo do hospital e se espalhou rapidamente por diferentes andares do prédio. elevando o total de mortos a 25. O desastre evidenciou falhas nas medidas de segurança e prevenção de incêndios, levantando questões sobre a adequação das instalações elétricas, manutenção dos sistemas de emergência e os protocolos de evacuação em caso de sinistros.


















Este caderno é destinado a arquitetos, designs de interiores e todos aqueles que desejam saber mais sobre o conforto térmico para projetos residenciais e comerciais leves.
Toda a edição um tema específico e de interesse. Vamos entrar?








No mercado de ar-condicionado há quase vinte anos, o engenheiro traz toda a sua expertise para um novo modelo de negócios na Elgin, e garante: vai brigar pela liderança do mercado.
Por Cristiane Di Rienzo
nderson Bruno é daquelas figuras que dificilmente passam despercebidas e isso não é apenas por conta de sua altura, que desponta da maioria – mais de 1, 90m. Anderson é rápido, inteligente, visionário e não para de pensar em como fazer melhor, de forma diferenciada, aquilo que já faz muito bem. A distinção é que Anderson também é movido a paixão, pois quando acredita em algo, toma para si aquele compromisso, como se fosse dele. Quase um desafio. E na realidade o é. Muitos dos seus trabalhos realizados pelas empresas por onde atuou, têm a sua marca: movimento, foco, liderança, entusiasmo, e exclusividade, que depois pode deixar de ser, já que acaba sendo absorvido pelo mercado, mas, geralmente quem abre a porta para o novo – assim como alguns outros executivos - é ele: Anderson Bruno, engenheiro elétrico,
CDR: Anderson, vamos iniciar pelo balanço de um ano na Elgin?
AB: Na área de ar-condicionado, eu respondo que já vim de uma escola que trabalha com a tecnologia inverter há mais de 7 anos. E quando eu cheguei na Elgin, vi que tínhamos uma participação nas vendas de mais de 60% em modelos on-off¹. O desafio foi desconstruir esse cenário para, a partir disso, reconstruir um cenário com sistemas do tipo inverter. O outro desafio que eu caracterizo como sendo muito maior do que o anterior, foi a transformação do mindset do time interno.
CDR: Por que isso?
AB: Na minha primeira semana na Elgin eu fiz uma entrevista com todos os meus liderados do time da área de Eletro para saber como eles viam a Elgin frente ao mercado, no tocante a tecnologia - em termos de percepção de marca e de entrega. O que foi que eu encontrei? A Elgin é uma empresa de pontualidade, boa qualidade, porém, de primeiro
atual diretor de Ar-Condicionado e Pequenos Eletrodomésticos da nacional Elgin. Anderson é o responsável por toda a equipe de vendas, marketing, comércio e pós-vendas e é o incumbido direto pela previsão do plano de produção da sua unidade de negócio, além de trabalhar em conjunto com a equipe de engenharia no desenvolvimento de novos produtos. Comunicativo, Anderson é sempre acessível ao seu interlocutor. Aí vai também a sensibilidade, que lhe é característica, fazendo com que não deixe de acompanhar os passos daquilo que implementa. Há um ano na companhia, Anderson concedeu essa entrevista com exclusividade que tem por objetivo fazer o balanço de sua atuação nesta empresa familiar, fundada há 72 anos, com cinco unidades de negócios e que quer cravar as primeiras posições do market share. Alguém dúvida?
preço. Ou seja, nós nos balizávamos embaixo da pirâmide e, a partir disso, o meu maior desafio foi desconstruir essa visão dentro de casa. O time me trouxe que nós éramos uma marca forte, respeitada, qualificada, mas que nós não éramos o “bom e barato”. Nós somos bons, baratos e melhores do que todas as outras tecnologias do mercado. Nós somos tecnologia brasileira, que é uma coisa extremamente rara e exclusiva do mercado. Este foi um tremendo desafio: desconstruir este mindset de todo o time, e, hoje, passado um ano tenho a certeza de que está todo mundo mais alinhado. Atualmente, as pessoas sabem que nós não nos nivelamos por baixo. Ao contrário: nós já nos nivelamos do meio para cima. Aliás, nós já miramos na ponta da pirâmide. Este foi um trabalho árduo, mas que teve que ser feito.
CDR: E por que havia essa linha de pensamento?
AB: Tínhamos esse mindset porque
nós entregávamos produtos, como por exemplo, o on-off – falando novamente em ar-condicionado. Atualmente, nós trabalhamos com equipamentos dotados com sistemas inverter, que é a categoria ouro do mercado e esse reposicionamento de mindset também se deu através da mudança na produção dos produtos. Nós tivemos que mudar tudo isso para nos adequarmos as novas necessidades.
CDR: E como fizeram essa mudança?
AB: Bem, começamos a trazer para o mercado todo o lineUp de equipamentos inverter, que utilizam o R32², que é um refrigerante mais ecológico. A Elgin é uma indústria brasileira, e foi a primeira a mudar todo o portfólio dos equipamentos de ar-condicionado para operarem com o fluido R32. Nós também tivemos que sair na frente, no que diz respeito ao treinamento de profissionais, porque nós éramos desconhecidos. Tivemos que mostrar a eles como usar os equipamentos,

precisávamos elucidar como utilizar o sistema de ar-condicionado da Elgin. Para isso desenvolvemos a “Caravana Elgin”, um evento que, no ano passado, rodou oito capitais do País e chegou a impactar quase cinco mil instaladores. No formato, levamos também nossos parceiros, que atuam no setor de ar-condicionado, para demonstrar as suas especialidades, como a Copeland, a Termomecânica, a Mastercool entre outros. Ou seja, esta é uma estrutura bem ampla e abrangente. E o mais interessante de tudo é que, em todas as praças por onde nós passamos, nós percebemos uma carência muito grande e, também, um desconhecimento da própria Elgin.
CDR: E a Seleção do Ar?
AB: O projeto a “Seleção do Ar”, é composto por 12 influenciadores, vindos do Brasil inteiro. São disseminadores de conteúdo técnico, utilizando os nossos produtos. Em março já os levei para verem o processo de modernização da fábrica. E ainda para que eles possam se comunicar melhor com o público, todos eles passaram por um treinamento com o jornalista da TV Gazeta, Celso Cardoso, para saberem mais sobre oratória e posicionamento frente a câmera. Também corrigirem vícios de linguagem e postura corporal. O objetivo é único: de que a informação chegue cada vez melhor na ponta.
CDR: E na parte de Eletro?
AB: Antes de tudo temos que dizer que a Elgin é o embrião de um segmento de eletroportátil, que tem o dobro de tamanho e o mercado mais consolidado do que o de ar-condicionado. E o interessante que, mesmo assim, nós também tivemos que desconstruir o mindset do time sobre a visão de eletroportáteis, e construí-lo novamente. Hoje as pessoas têm orgulho, têm prazer em utilizar e indicar um eletroportátil da marca Elgin. Esse foi o engajamento interno, a nossa primeira mola propulsora.
CDR: Pelo que você demonstra, me parece que houve uma revolução na forma como a Elgin se apresenta ao mercado?
AB: Isso. Esse foi um trabalho que nós viemos desenvolvendo nesses 12 meses. Também fizemos outras ações, como a “De Malas Prontas”, com o objetivo de mostrar que a






Elgin é uma indústria de alta tecnologia. Funciona assim: o profissional que instalar um equipamento Elgin, pode registrar a instalação em nosso Portal, mediante a nota fiscal. Aos instaladores que mais instalarem produtos Elgin, nós os levaremos para conhecer a nossa fábrica em Manaus (AM). Para se ter uma ideia, durante esse período, nós já levamos cerca de 20 instaladores para conhecer a nossa planta na Zona Franca. E nesse tour, os ganhadores puderam ver como nós produzimos o nosso equipamento e acompanhar demais etapas de produção, em nossa fábrica. Com isso eles tiveram a oportunidade de desmistificar que a Elgin é uma marca simples e tiveram a percepção da fábrica, do quanto a gente investe tecnologia. Outra ação deu-se na Febrava 2023, nós fomos premiados por termos o maior estande da feira, que somado a outras atividades faz parte de um projeto, desse primeiro ano. Mas tudo isso de acordo com a nossa agenda.
CDR: Anderson todas essas ações impactaram em quanto no crescimento de vendas da Elgin?
AB: Não cresceu o tanto quanto nós gostaríamos. De setembro de 22 a setembro de 23, crescemos + 40% acumulado, em vendas de ar-condicionado. Tivemos um problema de seca, entre os meses de outubro e novembro e, com isso, demos férias coletivas na fábrica, contudo, mesmo com dois meses a menos, crescemos 40%, ao ano.
CDR: Anderson você comentou que a Elgin tinha todo o seu portfólio de ar-condicionado voltado para sistema on-off. Atualmente como é que está essa conta? AB: 100% inverter.

CDR: E qual é a capacidade de produção de ar-condicionado Elgin?
AB: A capacidade produtiva da Elgin atualmente é 5.000/dia aparelhos. A produção é sazonal.
CDR: O lineUp é composto por quais equipamentos?
AB: Linhas de modelos Hi-Wall, Piso-Teto, Cassete 1 Via, Quatro Vias; Multi Split com a composição bi split e tri split. A nossa estratégia é o básico bem-feito. O menos aqui é mais. Nossas linhas compreendem modelos que vão de 7 até 20.000 BTU’s. Ainda, sobre Ar- Condicionado nós temos cortinas, climatizadores, fluidos refrigerantes, entre outros produtos. E na Feicon lançamos o frigobar e o freezer vertical, exaustores de ar para banheiro, para cozinha lavabo e umidificadores.
Nós temos uma linha composta por 180 equipamentos que diferem na tensão, tamanho e capacidade. A produção nacional é a cortina de ar, os climatizadores, os exaustores, o frigobar e o freezer; e toda a produção de ar-condicionado que é feita no Brasil, vem da fábrica de Manaus, excetuando o splitão.
CDR: E sobre o Centro de Treinamento inaugurado agora em maio? AB: O centro de treinamento (CT) é uma necessidade que está dentro da demanda. Cada vez mais nós precisamos capacitar os nossos parceiros instaladores. Toda vez que muda um lineUp de produtos, os instaladores precisam estar bem orientados e bem-informados sobre essas mudanças. O nosso Centro de Treinamento tem um uma meta de ser um CT tanto para climatização quanto para a refrigeração comercial, juntos na mesma estrutura, que está abrigada na fábrica de Mogi



das Cruzes (SP). Além dos treinamentos prático e teórico, também queremos dar a oportunidade para o instalador ter contato com a linha de produção. Como a nossa engenharia de produtos também fica em Mogi, numa única visita, o instalador além de se capacitar, poderá ver como o produto é feito e certificado, enfim ele terá todo esse universo à disposição. Tudo isso faz parte de uma imersão para que estes profissionais vejam o quanto investimos em tecnologia, pesquisa e desenvolvimento.
CDR: Como serão os cursos, os treinamentos?
AB: Nossa ideia é ter uma grade de cursos gratuitos, que serão ofertados por módulos. Dessa forma, teremos módulos básicos, intermediários e avançados. É claro que para o interessado conseguir o certificado, ele terá que completar os três módulos. Além disso, nós teremos, também, módulos exclusivos para os nossos credenciados, para que eles possam acompanhar todas as alterações, todas as nuances do desenvolvimento de nossas Linhas. Justamente por isso, o nosso credenciado tem dois anos de garantia no aparelho, ou seja: ele já tem um ano de garantia pela fábrica, mas por ser credenciado ele tem direito a mais um ano. E isso se converte para o usuário, que terá dois anos de garantia no equipamento de ar-condicionado se fizer a instalação do aparelho com um de nossos credenciados.
CDR: Anderson, como será a Caravana Elgin 2024?
AB: Ela será realizada com o dobro de Praças da edição 2023, ou seja, com 16 cidades que ainda não foram atendidas por nenhum outro





fabricante, como por exemplo Manaus (AM). Outra localidade nessas condições é Porto Velho (RO). Nós queremos sair do mesmo e fazer diferente. Para se ter ideia, já estamos sabendo de pessoas que estão comentando sobre a Caravana e dizendo, que vão pegar um dia de barco para poder ir ao evento da Elgin. Queremos ter esse público que não tem e não teve a oportunidade de receber informação treinamento de qualidade. Será uma apresentação a cada 15 dias e eu estarei em todos, excetuando em duas oportunidades em que eu estarei fora do País. Mas eu já apresentei todos, sem exceção. Eu quero ir nesta edição, e ouvir os instaladores.
CDR: E quais são as novidades para 2024 Anderson?
AB: Bem, uma das novidades é que nós estamos desenvolvendo um novo aparelho de ar-condicionado dutado, que é uma necessidade do mercado. Um split dutado, cuja premissa é de serem altamente eficientes para atender a norma de 2026, do InMetro. Ele passa de 5.4 para 7.6 para ter a eficiência mínima, pois o InMetro vai apertar cada vez mais os fabricantes para oferecer ao público os equipamentos mais eficientes. Isso é mais produtivo economicamente do que construir novas matrizes energéticas. E nós aqui da Elgin, já estamos trabalhando e nos antecipando para atender a norma de 2026. Esses equipamentos deverão ser lançados até o final desse ano de 2024.
CDR: Você comentou sobre as novas ações da Elgin para a área de Ar-Condicionado, também focando em novos modelos com geração de eficiência energética, desempenho, design, mudança do lineUp . Pergunta: a fábrica está preparada para toda essa alteração?
AB: Não, nós tivemos que readequar a fábrica também. Nós estamos investindo em ferramental, em indústria 4.0, e em inteligência artificial. Estamos fazendo diversas modificações na fábrica. Nós devemos apresentar um processo mais forte de modernização - do que normalmente é feito, até o final do ano e se isso se concretizar, dentro de um ano, nós vamos fazer uma inauguração formal. Nosso investimento é milionário, muito pesado na planta de Manaus. Não dá para dizer o


valor, não dá para dar detalhes. Mas estamos investimento muito forte na modernização da planta, que será atual, com muito mais eficiência e prevista para operar com essas novidades no final de 2024 ou começo de 2025. Isso depende mais de recebermos o ferramental.
CDR: Sobre os eletroportáteis, há a parceria com o chef Olivier Anquier?
AB: Sim, essa parceria já existe para eletroportáteis. Ele já é o nosso embaixador oficial para a Linha de eletroportáteis, desde fevereiro desse ano. Isso porque os eletroportáteis fazem parte do dia a dia do negócio dele, mas nós também não estamos deixando de considerar, pulverizar essa parceria para outras unidades de negócios. Estamos estudando. Voltando, a parceria do primeiro momento é para a linha de eletroportáteis, especialmente para cozinhas que é o core business dele.
CDR: Por falar em eletroportáteis, o que a Elgin está redesenhando para essa área?
AB: Bem, para a área de eletroportáteis nós estamos apostando fortes em três produtos, que representam 70% do mundo dos eletroportáteis: o primeiro, as fritadeiras, as air fryers, que estamos estudando aumentar de capacidade de 3 l, para 4,5 / 5l. Estamos fazendo toda a nossa composição, um estudo para aumento do parque instalado do lineUp de capacidade acima de 3 litros. Esse é o primeiro desafio, entre os maiores. Depois vem o eletroportátil que é mais comercializado em volume - mas não em valores -, que é o ventilador. Lançamos na Feicon o primeiro ventilador, sua fabricação ainda é importada, mas nós estamos estudando fabricá-lo no Brasil. É um mercado muito grande com 30 milhões de aparelhos/ ano. E terceiro, mas não menos importante é o mercado de liquidificadores, que representam 70% vendas, ou seja, um alto volume de vendas. Por isso estamos introduzindo diferenciais, como, por exemplo, os jarros. Não vamos trabalhar com copo de plástico, mas, sim com o jarro de vidro.
Nós vamos nessa linha de produtos, pois eu quero que os usuários, nossos clientes enxerguem a Elgin com produtos bons, de qualidade, eficiência, referência, mas que ele tenha poder aquisitivo para comprar aquele produto, pois a Elgin entrega muito com preço acessível é esse o caminho que a gente está buscando, o premium acessível. Essa é a frase.
CDR: Como a Elgin olha para o arquiteto?
AB: O nosso lineUp desse ano já foi com foco no arquiteto como, o cassete de uma via. Nós tiramos aquele branco leitoso e acrescentamos o branco fosco que é uma demanda do arquiteto - o mate, que é o fosco mesmo. Para atendê-los estamos resenhando a linha. Outro exemplo pensado no arquiteto é o split dutado, que eu já citei. Nós estamos trabalhando muito nesse modelo justamente porque é uma demanda de equipamentos para obras, projetos de alto padrão. Atualmente, o pessoal - mais do que nunca -, quer difusor linear e não quer saber mais de paredes aparentes.
CDR: E como o arquiteto chega no credenciado Elgin?
AB: Nós temos o nosso mapa de credenciados por cidade, município, estado, capital, localidade por região, de forma bem acessível: basta ele entrar em nosso site, verificar qual é a região que ele deseja ter atendimento para realizar o serviço, que o arquiteto obterá a relação dos profissionais que atendem aquela localidade. Lembrando que, quem trabalha com o nosso credenciado, ganha mais um ano de garantia no produto, é a garantia estendida.
CDR: Para finalizar, Anderson, o que você espera para a Elgin daqui a 5 anos?
AB: Quero que a Elgin seja uma empresa referência nas unidades de negócio em que nós estamos atuando. Ou seja: pensou em ar-condicionado, a Elgin tem de ser uma das duas marcas que vêm imediatamente à memória da pessoa naquele momento.

¹ O modelo on/off, porém, é conhecido como uma versão tradicional do split, sempre desligando assim que a
¹ O modelo é conhecido como uma versão tradicional sempre assim que a temperatura definida no controle é estabelecida no ambiente. Já o inverter fica sempre ligado, mas realizando os ajustes necessários para manter o clima agradável dentro daquele espaço ²éfiàfílidhidflb()léiddiiál ² O R32 é um refrigerante pertencente à família dos hidrofluorocarbonos (HFCs). Ele é considerado mais amigável ao jpgqpç meio ambiente do que outros fluidos utilizados em sistemas de ar condicionado e refrigeração, pois tem um potencial de aquecimento global (GWP, na sigla em inglês) menor. ³ A partir de 30 de junho de 2026, os fabricantes e importadores deverão comercializar, no mercado nacional, somente ³iddjhdfbiiddãilidil ³ A de 30 de 2026, os fabricantes e deverão no somente qg(,gg) condicionadores de ar split etiquetados com base nas classes de eficiência energética estabelecidas pelo InMetro










Pensado nas escolhas dos arquitetos e designers de interiores, a SEÇÃO VITRINE traz os lançamentos e as novidades dos eletroportáteis e da Linha Branca, como os equipamentos de ar-condicionado. Confira aqui os produtos, seus desempenhos e detalhes que levam ao Conforto – por vezes térmico -, com um “quê de Arquitetura".









Philco também coloca seus produtos na Vitrine e começa com a Adega PAD18I, perfeita para armazenar os seus rótulos favoritos. Com capacidade para 18 garrafas, controle de temperatura através de display digital e iluminação interna que facilitam a organização e visualização. Possui portas de vidro duplo anti-condensação, baixo nível de ruído e baixo consumo de energia. Seu design com acabamento inox e prateleiras deslizantes e reguláveis com detalhes em madeira deixa o ambiente mais moderno e repleto de estilo.
Já o Bebedouro com compressor PBE11 oferece água natural e gelada. É compatível com galões de 10L e 20L e possui sistema perfurador e bandeja removível, facilitando o uso no dia a dia. A marca garante que ele também gela mais rápido do que os convencionais, pois possui refrigeração por compressor e baixo consumo de energia. Possui sistema Easy Clean com nanotecnologia que evita a proliferação de bactérias e é fácil de limpar.
E por último, ressaltamos a Coifa PCO90I, que possui design cle-

an e elegante para a sua cozinha. Com dois modos de operação, o depurador e o exaustor é ideal para cooktops ou fogões de até 6 bocas. Tem Painel Touch rápido e prático com 3 níveis de velocidade à sua escolha. Funciona por dupla filtragem, com filtro de alumínio e carvão ativado e possui iluminação em led embutida.






ntre os principais destaques da nacional Elgin, empresa com mais de 70 anos de mercado, está a área de Climatização que apresenta lançamentos equipamentos de Ar-Condicionado com os modelos Ar-condicionado Bi e Tri Split Inverter Wi-fi, que refrigera de dois a três espaços por unidade, e Ar-condicionado High Wall Eco Dream Inverter Wi- Fi, cujo diferencial é a potência de até 36 mil BTUs, que garante maior capacidade de refrigeração. Ambos contam com o fluido refrigerante ecológico R-32, que possui os menores índices de impacto ao meio ambiente.
Já no segmento de Eletroportáteis, a marca está em processo de atualização e ampliação de portfólio. Vale a pena acompanhar! Aqui trazemos dois novos modelos de cafeteiras: Coffee Break 15 Xícaras e Family Coffee 30 Xícaras, assim como fritadeiras com maior capacidade, variando entre cinco, oito e 12 litros, cada uma com um diferencial único, como painéis digitais e o mais bacana: nas cores da tendência 2024.
Para a área de Iluminação, parte do segmento de Bens de Consumo, a Elgin apresenta novidades versáteis como










a Lâmpada Pétala e versões na cor preta dos produtos Luminária EcoSpot, tartaruga e painéis de sobrepor e embutir, assim como as linhas de Casa Inteligente, Filamento de Led colorida, Perfil Led e a ampliação do portfólio de Disjuntores. Um luxo! O foco dos novos produtos está em oferecer eficiência energética, conveniência, segurança e praticidade aos usuários, sempre em sintonia com os mais recentes avanços tecnológicos para transformar a maneira como as residências são construídas e como os sistemas elétricos são projetados.




TCL arrasou no evento de divulgação do seu line-up 2024 (vide página 12), composto da Linha marrom – confira em nosso Portal: www.mundodoaredarefrigeracao. com.br. Na Vitrine destacamos a chegada do seu primeiro produto da categoria de linha branca, a geladeira MultiDoor TCL C516CDN, marcando a expansão do portfólio da marca e a entrada no segmento. Com capacidade total de 516 litros, o modelo possui tecnologia Twin Eco Inverter e economia de energia atingindo classificação A+++ no Inmetro. Além disso, possui Espaço Flex, Metal Cooling, gavetas Multi-Zone, baixo nível de ruído, fluxo de ar inteligente e painel touch, além de contar com garantia de 10 anos no compressor e um ano no produto. Já a geladeira MultiDoor TCL C589CDN, tem capacidade de 589 litros, conta também com a tecnologia Twin Eco Inverter. Além disso, possui o Espaço Flex, com flexibilidade para o armazenamento de qualquer tipo de alimento. De alimentos frescos a uma cervejeira de até 79 litros, você controla a




















temperatura como preferir, já pensou?! Já com o Metal Cooling, a temperatura é distribuída de forma uniforme, e a Zona de Baixa Umidade é ideal para frutas e vegetais que são mais propensos à deterioração quando expostos à umidade excessiva.
Ainda na seção Refrigeradores, a TCL mostra a Side by Side TCL C516SBIMN Com capacidade total de 516 litros e disponível na cor inox, a geladeira Side by Side TCL C516SBIM também possui tecnologia Twin Eco Inverter, dispenser de água na porta, fornecendo água filtrada, com alimentação diretamente pelo suprimento de água na rede. Além disso, vem com o Ice Maker, que é o dispenser que fornece gelo picado e em cubos, bem como armazena até 1,5 kg de gelo. Com resfriamento ultrarrápido, ele atinge rapidamente a temperatura desejada, mesmo que seja adicionada mais carga ao refrigerador. O Metal Cooling distribui a temperatura da geladeira de maneira uniforme também, contribuindo com a conservação dos alimentos. Para a lavanderia, há a Lava & Seca C311WDW na cor branca e a C311WDS na cor prata: Com capacidade de 11Kg para lavagem e 7Kg para secagem, o modelo possui Tambor em formato colmeia, protegendo os tecidos mais delicados, com tecnologia exclusiva de secagem. Lavagem a seco, sem a necessidade de utilizar água e detergente. Motor BLDC Inverter, muito mais potente com menor consumo de energia, além de programação flexível, da qual é possível escolher o horário da lavagem de acordo com a rotina de cada consumidor.
Na categoria climatização, o Multi
Split Inverter que vem com a condensadora disponível nas capacidades de 18.000, 27.000 e 36.000 BTU/h, e a evaporadora de 9.000, 12.000, 18.000 e 24.000 BTU/h, o modelo conta com o modo ECO,

sistema 100% DC Inverter, conexão Wi-Fi e controle por aplicativo, Alerta Limpa Filtro, sistema de Autolimpeza, proteção anticorrosão, ampla faixa de operação e muitas outras features que podem ser consultadas em detalhes no site da marca.
Split Cassete Inverter: O modelo marca a expansão do portfólio da TCL para a linha comercial leve, tem produção nacional na fábrica da TCL em Manaus (AM) e está disponível nas capacidades de 36.000 BTU/h e 55.000 BTU/h. Com sistema 100% Inverter e menor nível de ruído, sua unidade evaporadora possui distribuição de ar 360°, distribuindo o ar de maneira uniforme. Com serpentina de cobre, modo turbo, fácil instalação e muitas outras features de destaque.
TCL FreshIN 2.0 Inverter: Segundo a marca, o modelo é capaz de renovar as taxas de oxigênio com uma vazão de até 60m3/h e manter um controle da umidade do ambiente interno, para níveis desejados de qualidade do ar interno. Além disso, possui função esterilização, filtro, auto limpeza, alerta limpa filtro e uma série de outros benefícios.








LG já tem tradição em Lava e Seca que além do desempenho, são apaixonantes. Em abril, trouxe sua nova linha de Lava e Seca, que agora apresenta mais capacidade em tamanho compacto, que, segundo a marca, garante a otimização do espaço da lavanderia dos consumidores. Os modelos que anteriormente possuíam 11kg e 13kg, agora possuem 12kg e 14kg de capacidade respectivamente, mas mantendo o mesmo tamanho de um modelo compacto de 11kg. Muito bom, né? Segundo a empresa “é mais capacidade e espaço suficiente para lavar itens volumosos em casa, como edredons, toalhas, almofadas e bichos de pelúcia, e economizar com a conta da lavanderia”. A LG informa, também que “os produtos contam com a Inteligência Artificial AIDD™,
responsável por analisar automaticamente o peso e a textura dos tecidos dentro do cesto e escolher o melhor padrão de lavagem para as roupas”.
Dotada com a tecnologia
Steam da LG que, por meio da lavagem com vapor, promete eliminar 99,99% dos ácaros e bactérias, além de diminuir em até 30% os amassados das roupas. As novas Lava e Seca contam com exclusiva porta de vidro temperado, resistente a impactos e altas temperaturas e tambor 100% em aço inox. Através do aplicativo LG ThinQ, o usuá-
rio pode controlar a máquina à distância e fazer o download de mais de 30 ciclos adicionais de lavagem, como edredom, uniforme escolar ou lingerie, por exemplo. O motor Inverter Direct Drive™ das máquinas possui 10 anos de garantia.



Fotos: divulgação.
MANSUR HADDAD, CEO da América do Sul
Expositora na Feicon 2024, a Armacell fez parte do espaço da ProAcústica - Associação Brasileira para a Qualidade Acústica, estreitando ainda mais a parceria entre a tecnologia de seus produtos e os setores afins. Durante o evento, o CEO para América do Sul da companhia, Mansur Haddad, integrou o time e fez questão de marcar presença nesta, que é uma das maiores feiras do setor da construção civil.
A Revista Mundo do Ar Condicionado e da Refrigeração, que visitou o evento aproveitou e conversou com Haddad, que além das estratégias para este 2024, falou sobre o aumento da capacidade fabril da planta em Santa Catarina, a atuação da empresa em segmentos distintos e ainda, sobre a recomposição do organograma para receber Marcelo Lemes, que, conforme as suas diretrizes, comandará a nova diretoria de Vendas, Marketing e Engenharia . Abaixo, os principais trechos desta entrevista. Confira!
Por Cristiane Di Rienzo

Mundo do Ar e da Refrigeração (MAR): Abril de 2024. Qual é o momento atual da Armacell no Brasil?
Mansur Haddad (MH): A Armacell é a empresa líder no mercado de isolamento térmico, ou seja: nós oferecemos ao mercado a Linha de elastoméricos e a Linha de polietileno e, em ambas as Linhas, nós somos líderes de mercado. Vale destacar que nós passamos por um processo de consolidação de 2016 a 2018, que foi uma aquisição importante no Brasil: a Polipex. Com ela, conseguimos criar um complexo produtivo em

São José, na Grande Florianópolis (SC) composto por duas fábricas. No ano seguinte, em 2019, exatamente no final do ano, foi quando eu entrei e assumi a diretoria da Armacell América do Sul. De lá para cá, a Armacell cresceu muito e fortaleceu a sua posição de liderança no mercado. E hoje a Armacell está diversificando os seus negócios.
MAR: De que forma?
MH: Bem, além de atuarmos no setor de HVACR (aquecimento, ventilação e ar-condicionado, na sigla em inglês), que é o coração do nosso negócio, nós também estamos diversificando nossa atuação, para a área de acústica, que são os isolamentos acústicos, que estão sendo apresentados na Feicon. Aliás, nós chamamos de construção civil, todas as aplicações que não são do setor de ar condicionado, pois são diferentes e, por isso, estão desassociados da nossa área do ar condicionado. Outro segmento em que atuamos é o ramo de petróleo e petroquímica, no qual apresentamos diversificação de produtos. E, por fim, o portfólio que fabricamos para o setor automotivo, que nos tem apresentado um grande crescimento. Portanto, ao mesmo
tempo em que nos últimos anos nós crescemos muito e mantivemos a nossa liderança no mercado de HVACR, nós também diversificamos os nossos negócios para outras linhas de produtos voltados para novos segmentos em outros mercados.
MAR: Essa diversificação vem a partir da Matriz (Alemanha), ou é uma oportunidade criada por conta da geolocalização?
MH: Tem um pouco de tudo. Por exemplo, a construção civil tem sido uma oportunidade, uma iniciativa local. Mas, por outro lado, tudo que tem a ver com a área de petróleo, óleo e gás é uma ação global. Já o automotivo é uma determinação mais local do que global até porque não são todas as unidades da Armacell que estão presentes no setor automotivo. Temos sim, uma presença muito forte nos Estados Unidos e, embora estejamos multiplicando o modelo americano para cá, todavia estamos desenvolvendo uma ação independente nessa condução. Ou seja, trabalhamos de uma maneira muito independente na área de automotivos e o que nós podemos aprender com a matriz ou mesmo com os Estados Unidos, estamos aprendendo.
MAR: Você citou que a Armacell teve um crescimento importante desde a sua entrada na companhia, que foi no ano de 2019. Qual é a porcentagem desse crescimento?
MH: São dois dígitos muito altos.
MAR: Quanto, por exemplo?
MH: Muito alto. A bem da verdade, a Armacell cresceu mais do que dois dígitos: foi na ordem de 120%, consolidado em 2021, 2022 e 2023. Estes foram anos importantes para a Armacell, pois representou não apenas o seu crescimento, mas, também, o amadurecimento do nosso time.
MAR: Vamos falar um pouco das novidades que envolvem a linha dedicada ao setor de HVACR?
MH: Sim. As nossas linhas de elastomérico e polietileno existem há muito tempo e apresentam pequenas evoluções. A tecnologia Armacell já é muito consolidada, no mundo todo. Haja vista que a Armacell é líder de mercado em muitos dos países em que atua. Quanto as novidades para o setor de HVACR, nós teremos sim, que vão chegar por aqui, mas que ainda eu não posso revelar, por conta de que alguns países já estão lançando essas tecnologias primeiro por lá e, por aqui, elas devem chegar por volta de 2025 e 2026. Mas, em se tratando de boas notícias, o que eu posso falar e que é muito importante para o segmento, é que a Armacell está aumentando a sua capacidade fabril na área de elastomérica, em 40%, já a partir
deste março 2024 até junho de 2025, e isso se deve a adaptação da Armacell a nova realidade do mercado. Explico: como nós crescemos muito, a nossa planta ficou um pouco mais apertada, portanto, fizemos novos investimentos para aumentar a nossa capacidade fabril. E isso é importante para o mercado, para que ele tenha conforto e segurança em trabalhar com a Armacell, que pode crescer junto com ele.
MAR: A expansão da capacidade fabril envolve a estrutura?
MH: Não. Nós estamos expandindo a linha de produção, que envolve a melhoria de processos e mais investimentos em novos equipamentos.
MAR: O senhor comentou que neste momento a Armacell atua em quatro frentes: HVACR, Acústica, Construção Civil e Óleo & Gás. A partir delas, qual é a representatividade da companhia nos referidos mercados, no panorama sul-americano?
MH: O segmento em que estamos mais embrionários, é esse aqui o da construção civil. Por outro lado, nós já estamos crescendo de uma forma muito forte na área do automotivo; e no segmento de óleo gás também estamos tendo uma presença muito robusta, pois é um setor que cresceu muito nos últimos anos e, no momento atual, este setor pode ser descrito como empoderado. Para se ter uma ideia, nós já entregamos uma obra grande na Refinaria Abreu e Lima (RNEST),

em Pernambuco. E agora estamos desenvolvendo uma obra muito maior na mesma refinaria. Também participamos de um projeto da Braskem; além de termos realizado obras para clientes da Argentina e da Colômbia, portanto, esse segmento está crescendo bem.
MAR: As ações realizadas em outros países da América do Sul são todas geridas a partir do Brasil?
MH: Sim, tudo é feito a partir do Brasil. A Armacell do Brasil comanda a América do Sul, já o Centro América não é conosco. Ou seja, Caribe e México são gerenciados pelos Estados Unidos. Nós cuidamos das fronteiras da Colômbia e da Venezuela até o sul do Chile e da Argentina. A América do Sul é composta por 13 países, nós cuidamos da operação de dez. E o Brasil é amplamente dominante, tanto por uma questão de território quanto de população. Um exemplo é a Feicon, que está tendo uma visitação incrível com clientes qualificados. Isso significa que a construção civil deve apresentar bons negócios, bons números. Nós estamos muito otimistas.
MAR: Nós sabemos que o mercado da construção civil já está bem aquecido, pois vemos muitas construções despontarem o tempo todo nas grandes cidades. A partir desse cenário e voltando o foco para a Armacell, o senhor comentou que a expectativa de crescimento da companhia, para esse mercado, gira em torno de

20%. Qual é a estratégia da empresa para atingir esse objetivo?
MH: Bem, nossas estratégias incluem, entre outras o lançamento do aumento de portfólio; também a presença no mercado com o comercial. Ainda, continuamos investir em nossa área de Engenharia e em nossa área de Especificação. E por falar nela, criamos uma estratégia de especificação geográfica, em que o nosso gerente de Exportação tem a missão de realizar um trabalho muito mais aprofundado na América do Sul. Mas, o mais importante: todas essas estratégias estão atuantes ao mesmo tempo, convergindo entre si para que possamos atingir o nosso objetivo.
MAR: O senhor citou “presença no mercado com o comercial”. O que é exatamente?
MH: Nós estamos com um novo diretor comercial que iniciou agora em abril, ele já está atuante. Trata-se do engenheiro Marcelo Lemes, que vem para liderar a nossa área de vendas, do que chamamos de Advanced Solutions. O Marcelo tem um grande conhecimento de equipamentos e de mercado. Só na área de HVACR ele acumula 30 anos de experiência. E eu estou muito otimista com a sua chegada. Ele entra para fortalecer o nosso time comercial. Tanto, que o nosso departamento que tinha status de gerência passou a ser diretoria, a partir do momento em que convidamos o Marcelo Lemes, para dirigi-la.
MAR: Há quase cinco anos de sua atuação a frente da companhia, a Armacell deu um salto: cresceu 120%, fatura R$150 milhões/ano, emprega cerca de 200 pessoas e fez do Brasil o grande centro fabril de operações da América do Sul, e que agora está se preparando para aumentar sua capacidade industrial em 40%. De que forma a Armacell Global enxerga as operações em nosso País?
MH: De fato, há 3, 4 anos nós passamos a ter uma maior agressividade nas operações América do Sul, o que inclui o Brasil. E digo que até para o nosso padrão interno, a Armacell América do Sul
virou uma referência. Não em tamanho, porque em outros países, ela é maior. Mas nós passamos a ser uma referência em muitos aspectos para a Armacell global. Portanto, esse foi um trabalho de qualificação, de amadurecimento do time e de qualidade junto ao cliente, colocando-o dentro da organização, tudo isso foi feito entre outras realizações.
MAR: Pode considerar isso um desafio?
MH: Sem dúvida, para você ter uma ideia eu tive que me mudar
de casa eu ir para Florianópolis, que era onde precisava resolver muitas questões. E estou de volta a São Paulo. E para mim esse momento é importante, pois aqui é a locomotiva do mercado. Também para conhecimento estamos localizados agora no bairro de Pinheiros e temos recebido muitas visitas do exterior e todos eles ficam muito bem impressionados com a performance da Armacell South America, o que indica que o caminho que nós temos traçado até agora tem apontado sucesso, o que é muito gratificante.
A Armacell América do Sul iniciou suas operações no Brasil em 1995, com a instalação da fábrica na cidade de Pindamonhangaba, interior de São Paulo. Desde então, a empresa tem participado do desenvolvimento de vários setores da indústria brasileira, fornecendo soluções em isolamentos térmico e acústico. Atualmente, a empresa tem 24 plantas em 16 países em quatro continentes: Américas, Europa, Ásia e Oceania.
Com a aquisição da empresa PoliPex, a Armacell deu um passo importante para o crescimento no mercado local e na América do Sul, transferindo a fábrica de Pindamonhangaba para a cidade de São José, em SC, onde concentrou toda a sua produção. Construiu modernas instalações da sua primeira linha contínua de produção de isolamentos térmicos flexíveis em espuma elastomérica, tornando-se a única fabricante desses materiais na América do Sul. O que impulsionou isso foi a necessidade de concentrar a produção numa unidade só e, também, um incentivo fiscal oferecido por Santa Catarina na importação de matéria-prima. Atualmente, a Armacell é a única produtora da América do Sul de espumas elastoméricas flexíveis para isolamentos avançados, usados em sistemas de ar-condicionado, aquecimento, tubulações, construção civil, empresas de petróleo e gás e outras. Também faz espumas de engenharia usadas em sistemas de geração eólica, automotivo e transportes. A fábrica que era a PoliPex produz itens de polietileno para os segmentos de lazer, ginástica e outros. Entre os produtos estão espaguetes de piscina, mantas isolantes para camping, além de tubos de proteção e segurança. A distribuição nacional dos produtos nos pontos de venda - comércio varejista de material de construção, home centers e lojas especializadas - é feita por dois Centros de Distribuição.




A responsabilidade da Engenharia e da Arquitetura no bem-estar das pessoas, na produtividade e o combate a doenças contagiosas transmitidas pelo ar ambiente.
Por Osny do Amaral Filho*
bordaremos neste artigo a importância da qualidade do ar interior, assunto de extrema importância e que afeta a qualidade de vida e saúde de toda a população. Salas fechadas onde vivemos a maior parte do dia necessitam ter um ambiente saudável para garantir a produtividade em qualquer tipo de atividade, evitar a disseminação de doenças transmissíveis pelo ar e por contato em superfícies e garantir o conforto térmico das pessoas.
O principal problema das salas fechadas é a ausência de “renovação do ar”, isto é, a retirada do ar degradado, que é produto da presença de pessoas em seu interior, visto o fenômeno do metabolismo da respiração, onde ocorre a queima do O2 (oxigênio) e a eliminação de CO2 (dióxido de carbono) para o ambiente. A baixa do nível de oxigênio e o excesso de dióxido de carbono causam desconforto crescente nestes ambientes fechados, afetando as pessoas que sentirão sonolência, dores de cabeça, letargia, entre outras indisposições, causando a queda no desempenho das atividades, especialmente nas profissionais.
O limite de medição de CO2 para a aceitação do nível de qualidade do ar é de 1.000ppm (partes por milhão), sendo a quantidade encontrada no ar exterior de 450ppm. Quanto aos efeitos maléficos ao
corpo humano a concentração máxima admitida de gás carbônico não pode passar de 3.500ppm. Os gráficos abaixo mostram a evolução dos níveis de O2 e CO2 com e sem sistemas de renovação de ar.


O ar de ventilação é aquela porção de ar externo (outdoor) insuflado, mais o ar de recirculação (indoor) que é exaurido para o exterior com o propósito de manter aceitável a qualidade do ar interior.
A Renovação de ar interior de salas - A “renovação do ar” consiste na entrada de ar externo filtrado (insuflação) e da saída do ar interno degradado (exaustão) que devem ocorrer de forma simultânea conforme a figura 1 que é parte da ASHRAE Standard 62.1 – Ventilation for Acceptable Indood Air Quality, que traz a seguinte definição e associa a figura abaixo:



SÍNDROME DO EDIFÍCIO DOENTE – SED
A portaria nº 2.523, de 28 de agosto de 1998 do Ministério da Saúde define a SED como segue:
“i) Síndrome dos Edifícios Do- Síndrome dos Edifícios Doentes: consiste no surgimento de sintomas que são comuns à população em geral, mas que, numa situação temporal, pode ser relacionado a um edifício em particular. Um incremento substancial na prevalência dos níveis dos sintomas, antes relacionados, proporciona a relação entre o edifício e seus ocupantes.”
SED foi reconhecida pela primeira vez em 1982, pela Organização Mundial da Saúde, onde casos graves de saúde ocorreram em edifícios comerciais com salas fechadas e sem ventilação (renovação de ar). Em 1976 cerca de 600 veteranos se
alojaram em um hotel Bellevue-StratfordHotel, localizado na Filadélfia/USA, palco de uma das piores tragédias médicas do século XX relacionadas ao fator qualidade do ar interior, onde 221 pessoas internadas com doenças respiratórias e 34 mortes; a partir deste fato os primeiros estudos e providências foram realizadas.
Tem ocorrido ao longo dos anos uma série de acidentes fatais com pessoas em razão de estarem em ambientes fechados e sem renovação de ar (especialmente durante o inverno), como consequência da saturação do ar ambiente por gases letais provenientes da queima de GLP – gás de cozinha, em aquecedores de água ou de ambientes, em fogões de cozinha, do uso de carvão vegetal em churrasqueiras, de lenha para queima em fogões. Estas situações acabam reduzindo drasticamente o O2 (oxigênio do ar) e produzindo CO (monóxido de carbono), além de outros COVs (Compostos Orgânicos Voláteis), levando indivíduos a uma morte silenciosa sem que percebam. Motivo: falta de renovação do ar ambiente. Ocorrências que podem ser evitadas com um sistema de renovação de ar.

Aquecedores de água instalados dentro de salas fechadas sem renovação de ar são potenciais contaminantes com gases letais.
soas. Há leis nacionais, como a Lei do PMOC – Plano de Manutenção, Operação e Controle para os ambientes climatizados (Lei 13.589 de 01/2018, ainda em fase de regulamentação) que é processo maior para exigir a qualidade do ar em ambientes fechados. Cada estabelecimento comercial ou público que tiver instalado aparelhos de ar-condicionado com capacidade de refrigeração acima de 60.000 BTU’s/h deverá ter o PMOC, que requer um “responsável técnico” - um engenheiro mecânico, para elaborar o plano e colocar em marcha as manutenções preventivas e corretivas dos aparelhos e dutos de distribuição do ar. É necessária a emissão de uma ART junto ao CREA para a regularização da atividade.

Aparelho de Condicionamento de Ar com e sem manutenção adequada.
ões, instalações hospitalares, quartos de dormir e tantos outros, são os ambientes onde os ocupantes passam mais de 90% do seu dia, e precisam da qualidade recomendada do ar interior. Por sua vez, as pessoas usuárias destes ambientes não têm conhecimento técnico sobre qualidade do ar, e assim, não conseguem perceber os riscos e malefícios da baixa qualidade do ar interior, colocando suas vidas em risco constate com a ocorrência de mal-estar, transmissão de doenças por vírus, bactérias entre outros, que acabam causando grandes prejuízos econômicos pelo absenteísmo.

A questão da renovação do ar ambiente é de suma importância para a qualidade de vida das pes-
Normas técnicas da Associação Brasileira de Normas Técnicas (ABNT), a Resolução nr. 9 da Agência Nacional de Vigilância Sanitária (ANVISA) são os princípios mandatórios deste processoe internacionais, como as normas e regulamentações da American Society of Heating, Refrigerating and Air-Conditioning Engineers (ASHRAE). No Brasil a aplicação do PMOC com os respectivos índices de qualidade do ar interior, deve ser supervisionada e fiscalizada pelas Vigilâncias Sanitárias (Anvisa), como, também, pelos Conselhos Regionais de Engenharia e Agronomia dos diversos estados, que fiscalizam os engenheiros responsáveis técnicos e o documento ART (Responsabilidade Técnica) para cada projeto, mas, estas fiscalizações são ainda parciais não abrangendo todas as edificações e os diversos ambientes fechados. Salas de aula, auditórios, escritórios, consultórios médicos, salas de espera, teatros, salas de reuni-

• Equipamentos de Renovação de Ar - ventilação mecânica. Sistema tecnicamente ideal, pois, se consegue calcular o número de renovações de ar da sala, conforme estabelecem as nomas técnicas, em função do número de pessoas no local.

Outro fator extremamente grave da falta de renovação do ar é a transmissão de vírus e bactérias. Uma pessoa infectada pode exalar quantidades significativas de vírus e bactérias que ficam circulando no ar em micro gotículas, flutuando e ocupando todos os espaços, fazendo com que outras pessoas respirem este ar infectado, o que causará a transmissão inevitável de doenças. Como a grande maioria das instalações de convivência humana em salas fechadas não tem mecanismos de renovação de ar, aliado a falta de conhecimento e preocupação das pessoas com relação a este tema, temos como fator principal do contágio e transmissão de doenças respiratórias; basta um dentro de uma sala de aula sem renovação de ar estar com uma gripe, por exemplo, que vários serão infectados e ficarão doentes também.
Uma tecnologia recentemente chegada ao Brasil é a atomização do ar interior com peróxido de hidrogênio (H2O2), chamada de tecnologia ativa de oxidação avançada. Este elemento natural do ar em concentração de 0,2 a 0,3 ppm é gerado a partir de equipamentos que transformam o H2O e o O2
A RESPONSABILIDADE DA ENGENHARIA E DA ARQUITETURA COM A SAÚDE E BEM-ESTAR DA COMUNIDADE
Para as avaliações, projetos e responsabilidade técnica o Engenheiro Mecânico é quem está habilitado à prestação de serviços nesta especialidade; porém, todas as demais áreas da engenharia e arquitetura estão intrinsicamente envolvidas com os espaços fechados de convivência humana e assim todos são responsáveis juntos as seus clientes e a comunidade em informar sobre este tema e na elaboração de soluções de renovação de ar e biossegurança.
Algumas observações importantes a serem seguidas para garantir a melhor qualidade do ar interior e assegurar a saúde e bem-estar dos ocupantes:
• O Plano de Manutenção, Ope-
do ar em peróxido de hidrogênio (H2O2), tendo como máximo admitido no ar de 1,0ppm, podendo ser admitido até 5,0ppm por curtos períodos de tempo. O H2O2 ocupa todos os espaços das salas fechadas, eliminando e matando por oxidação instantânea vírus e bactérias suspensas no ar, contidas nas micro gotículas exaladas pelas pessoas através da fala, espirro e tosse. É um processo natural e auto reciclável, pois após a oxidação dos elementos do ar volta ser água e oxigênio. Os equipamentos são produzidos nos USA onde são largamente utilizados nos ambientes fechados, inclusive e especialmente em hospitais e nas instalações de saúde, visto a sua eficácia de 99% na eli-
minação dos patógenos. Também são eliminados por este processo: odores, fungos, compostos voláteis e alergênicos, tornando o ar interior limpo e seguro. Num teste prático realizado com o espirro de uma pessoa foi medida a velocidade de saída do jato de macro e micro gotículas da boca e nariz, que é de aproximadamente 160 km/h. Com a atomização do H2O2 no ar, quando este jato chega a 1 metro de distância, todos os patógenos estão envolvidos e oxidados, não trazendo assim a possibilidade de infecção à outras pessoas. É um processo altamente seguro sendo aprovado pelos principais órgãos de certificação da América do Norte.

ração e Controle – PMOC do Ar-Condicionado deverá estar implementado em todas as edificações públicas ou privadas para garantir o sistema de climatização limpo e higienizado;
• Contratar um engenheiro habilitado e registrado no CREA para elaboração dos projetos e implementação do PMOC;
• Implantar um sistema de renovação do ar ambiente com ventilação mecânica, como também avaliar condições para usa da ventilação natural que promova a renovação do ar interior;
• Abrir portas e janelas para garantir uma ventilação natural como primeira providência para minimizar os efeitos do ar degradado. Caso não haja condição de ter renovação de ar, proibir a permanência de pessoas no local;
• Implantar um sistema com equipamentos de geração de Peróxido
de Hidrogênio atomizado nos ambientes de modo a purificar o ar interior e garantir a biossegurança. Por fim, fica a observação sobre a responsabilidade da engenharia e da arquitetura quanto a saúde, bem-estar, qualidade de vida e produtividade das pessoas, assim, os projetos precisam ser realizados por profissionais especializados, a manutenção dos equipamentos de climatização precisa ser periódica através do PMOC. Os engenheiros e arquitetos devem cobrar e exigir estes processos.

*Osny do Amaral Filho - engenheiro mecânico, Mestre em Qualidade do Ar Interior (QAI); ex-conselheiro do CREA-SC; vice-Presidente do PNQAI (Plano Nacional de Qualidade do Ar Interior); diretor Técnico do CEAJ - CENTRO DE ENGENHEIROS E ARQUITETOS DE JOINVILLE; diretor da Abemec-SC; diretor Regional da ASBRAV-SC. OAF.QAI – ME de consultoria e projetos.




























O estilo de vida das populações urbanas tem mudado muito nas últimas décadas. O aumento do tempo gasto em ambientes interiores faz da Qualidade do Ar Interno um tópico de importância mundial. A Qualidade do ar interno (QAI) refere-se à qualidade do ar dentro e ao redor de edifícios e estruturas, especialmente no que se refere à saúde e conforto dos ocupantes do edifício. Compreender e controlar poluentes comuns em ambientes fechados pode ajudar a reduzir o risco de problemas de saúde.






Propósito: Formação de aliança entre organizações não governamentais, representantes da sociedade em diversas áreas do conhecimento e campos profissionais, como membros de um Plano Estruturado.
Apoie e divulgue o PNQAI www. pnqai.com.br
Mais de 30 associações juntas para promover a melhor qualidade do ar. Saiba como participar: pnqai@pnqai.org.br
NA PRÓXIMA EDIÇÃO
TRAREMOS TUDO SOBRE A IMPORTÂNCIA DO SETOR DE HVACR NAS PADARIAS.
Aliás você sabia que de 60 a 70 % do investimento de uma padaria vai para equipamentos e soluções do setor do frio?
Pois é! Esta e outras informações na próxima edição. Imperdível!



Confira também entrevista exclusiva com a arquiteta Virgínia Sodré sobre a certificação Zero Water, lançada oficialmente no segundo semestre de 2023, pelo GBC Brasil, como sua contribuição ao Programa Global Advancing Net Zero, que prevê zerar as emissões de carbono na atmosfera provenientes do setor da construção civil até 2050 para o cumprimento das metas da COP 21 – Paris 2015.


@mundodoaredarefrigeracao mundodoaredarefrigeracao mundodoaredarefrigeracao mundodoaredarefrigeracao
@mundodoaredarefrigeracao mundodoarErefrigeracao mundodoaredarefrigeracao mundodoaredarefrigeracao mundodoaredarefrigeracao.com.br
NO MAIS: ENTREVISTAS, ATUALIDADES, LANÇAMENTOS E MAIS CONTEÚDOS DE INTERESSE PARA FICAR POR DENTRO DO MUNDO DO AR E DA REFRIGERAÇÃO.
www.mundodoaredarefrigeracao.com.br





Transformando ideias em engenharia sustentável










































Resfriadores de líquido
Chiller Scroll - RLAC-S



Variable load Chiller - VLC















Climatizadores de Precisão
Self Contained (CRAC) - CPA



Fancoil Água Gelada (CRAH)-CPC
Resfriamento entre racks - CPID


Compacto - CPM






















Conheça a linha de chillers oil free